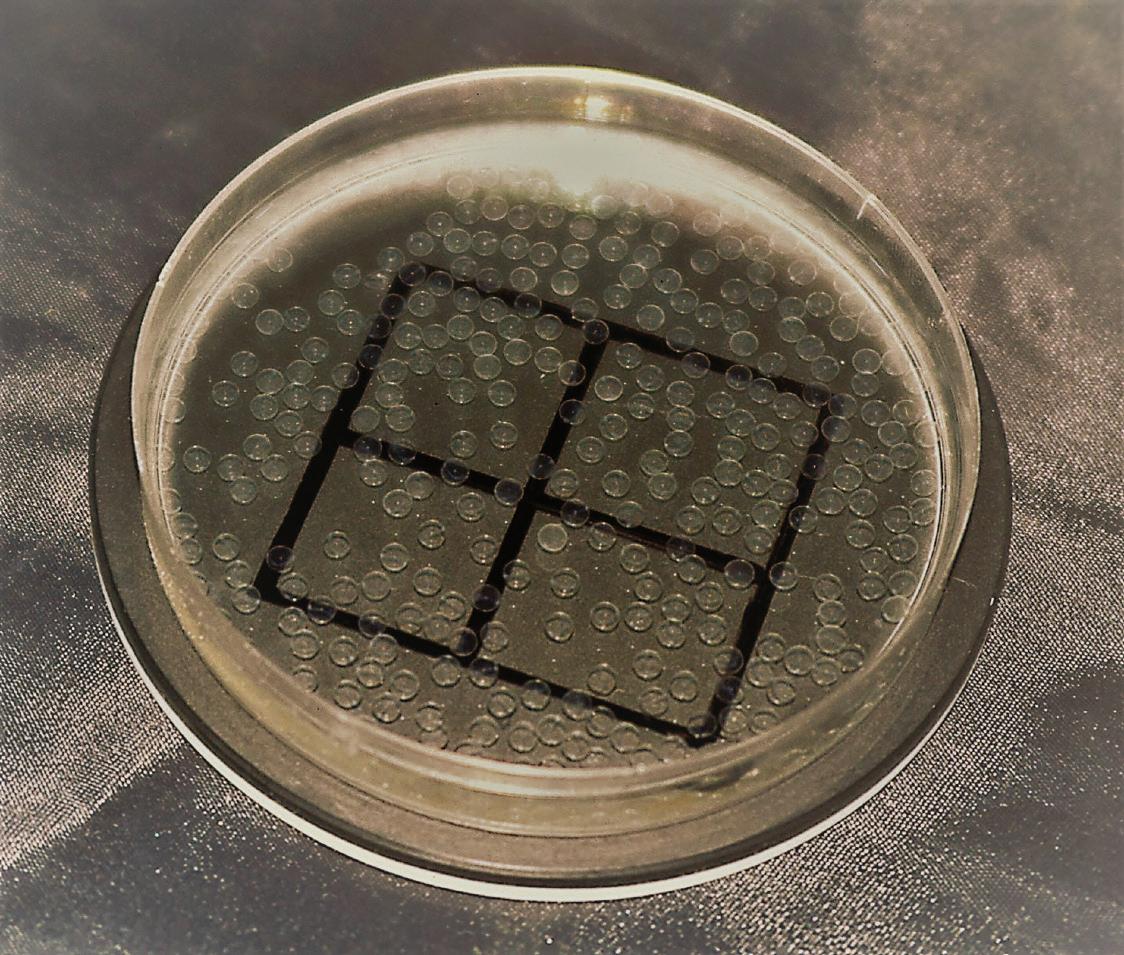

MONITORING SYSTEMS


Hatchery Feeds
Microbial Management
Optimizing Vaccination
Vol 9 Issue 1 2021 Vol 10 9 Issue 1 2021 Published by Aquafeed Media S.L.U. www.hatcheryFM.com info@hatcheryFM.com
10
CONTACT US
Editorial: editor@hatcheryFM.com
Editor/Publisher: Lucía Barreiro
Consulting Editor: Suzi Dominy
Assistant Editor: Marissa Yanaga
Conferences and webinars: info@hatcheryFM.com

Advertising enquiries/request media pack: sales@hatcheryFM.com
Accounts & all other enquiries: info@hatcheryfm.com

SUBSCRIBE
Digital editions are free to industry subscribers. You may also purchase print copies. Subscribe at HatcheryFM.com to receive your own digital copy of our publications.
https://bit.ly/HATCHERYSUBSCRIBE


HATCHERY FEED & MANAGEMENT VOL 10 ISSUE 4 2022 Contents 4 Interview with Alastair Barge 7 News Review 11 Hatchery Industry Outlook 2023 14 Start strong, stay strong 18 The art and science of broodstock feed 24 Can you save money by measuring oxygen or by optimizing your oxygen measurement in aquaculture? 27 Turbidity: An invaluable tool for understanding farm performance 33 Turning probiotic bacteria into an effective microbial management tool for shrimp aquaculture 37 Building robustness in the early stages of shrimp lifecycles 39 The unintended cost of water disinfection in RAS systems 42 Microbial water quality tools: Essential for maintaining an optimal and stable production environment 46 �Optimizing vaccination of fish 50 The carp polyculture microbiome: How to break the status quo 54 Calendar of events Columns 21 Gidon Minkoff - Marine fish hatchery automation 30 Tony Broadhurst - Don’t count your chickens... To read previous issues in digital format or to order print copies, visit www.hatcheryfm.com
Aquafeed Media, S.L.U., Ames, 15220 A Coruña, Spain. Copyright© Aquafeed Media, S.L.U., 1998-2022 All rights reserved. Privacy Policy & Terms of use HATCHERY FEED & MANAGEMENT
issue of the magazine.
support
to
our publications available
charge. I&V Bio 10 BioMar 17 Merck Animal Health ........................................... 20 Molofeed .................................................................23 Zeigler 26 Reed Mariculture ...................................................32 Cargill .......................................................................45 Megasupply 49 AquaFarm ...............................................................55 World Aquaculture Society ..................................56 FOLLOW US *Cover photo
We are grateful to the following companies for sponsoring this
Their
allows us
make
without
Contents
OPTIMIZING OXYGEN MEASUREMENT 24
How to save money by measuring and controlling oxygen levels in your fish farm.


HATCHERY INDUSTRY OUTLOOK 11
A look at the year ahead as aquaculture farmers are coping with high input costs and a likely weaker demand.
START STRONG, STAY STRONG 14 Novel microdiets and well-adapted zootechnics bring the production of marine fish larvae closer to completely eliminating the dependency on live feed.

EFFECT OF WATER DISINFECTION ON MICROBIOME 39
How to balance between removing pathogens and preserving beneficial microbes that are required to support fish and shrimp in RAS.

Hatchery Feed & Management Vol 10 Issue 4 2022 VOL 10 ISSUE 4 2022
HATCHERY FEED & MANAGEMENT
Alastair Barge, CEO of Otter Ferry Seafish
INTERVIEW with Alastair Barge
HFM: Founded in 1967, Otter Ferry Seafish is one of the longest-established aquaculture businesses in the UK. Would you briefly tell us more about the company’s journey?

AB: My father Ronald Barge and his business partner Iain McCrone saw a future for aquaculture as an extension of agriculture and an opportunity for farmers in the coastline on the west of Scotland. They started with rainbow trout in concrete raceways. As it used to happen, they ran out of freshwater and used recirculation and brackishwater to reach capacity. The trout naturally lead into salmon, since the hatching technique as a salmonid was very similar. The coastline at Otter Ferry was not suitable for early cage technology and being familiar with pumping saltwater, we built the first land-based salmon farm with 12 x 12m tanks and
grew 60 tonnes of salmon while the industry was still at 1,000 tonnes. As cages mastered the techniques, we built bigger tanks but could not compete. We specialized in salmon broodstock and smolt production but again, we could see vertical integration in the salmon industry and a shrinking of the third-party market. We started to look at other species, such as lobster, turbot, cod and halibut, with halibut ticking most of the boxes such as yield, FCE, growth and market position.
HFM: Being a tricky species to farm, how did you solve the early stages issues in halibut and why did you decide to continue producing this species? How about all-female stocks?
AB: We started with halibut in 1991. We didn’t know that halibut was tricky when we started. That was
Hatchery Feed & Management Vol 10 Issue 4 2022
discovered quite quickly by Seafish Industry Ardtoe and three other hatcheries, all working on the species at the same time as us. Marine hatchery was a big change in the process and culture.
The F1 generation was blighted by weaning broodfish from wet diets onto dry manufactured diets which proved to be unsuitable and led to a worldwide dip in the production of juveniles. The tricky bit of the cycle is maintaining larval yolk sac stability and avoiding variable larval quality. In general, in fish farming, it’s never the fish’s fault, it is always the operators’ and the system’s fault and that is the challenge. After first feeding, halibut is particularly robust and suitable for the farmed environment.
After 30 years, we are still mastering the process. The generation time is ten years to get a good producing female. We are into F3 and have been all-female for the last five years. The all-female culture transforms the on-growing yield per juvenile and it is a shortcut to a selective breeding program.
HFM: With the increase of sea lice episodes in salmon, ballan wrasse emerged as an alternative for salmon delousing. What are the main highlights of this species? What is your current survival rate and how do you manage to improve feeding?

AB: Having entered the marine hatchery world with halibut it opened up the opportunity for other species. We didn’t realize how tricky halibut was and
wrasse, although difficult, was considerably easier than halibut. Every species has its challenges. For wrasse, it took us three years to domesticate the wild broodstock establishing harems and develop the male side of the population.
Natural spawning, incubation and larval production were relatively straight forward and initiation of feed on rotifers and growing on Artemia uncomplicated.
Weaning was the next hurdle to overcome, with fish refusing to eat anything other than Artemia and willing to die rather than wean. We tried to wean onto several highly rated weaning diets. Our best results eventually came from a formulation from Nofima. We still use that diet formulation at critical times and have found the mixed regime has both increased survival and reduced deformity.
Our strategy is to produce more fish through improved survivals, currently 10% to weaned juveniles. We believe that with the combination of larval quality and optimum prey density, we can reach 20%.
HFM: With the closing of the lumpfish production cycle, a new species was added to the hatchery. What have been the key points for a successful larvalrearing process?
AB: We have reached a high level of survival in the hatchery relatively quickly and so the scope for improved yield in the hatchery is more marginal. Good fish farming practices of feed regime, grading and
Hatchery Feed & Management Vol 10 Issue 4 2022 5
meticulous excellent quality of fish. Lumpfish are reared on a protected flow-through system and, geographically, we are well positioned to supply the Scottish producers. Both these factors lead to reduced stress and a successful transfer of the lumpfish to the cage environment.

HFM: For all these species, are you running any breeding programs?
AB: The generation time for wrasse and halibut is ten years. Currently, we have halibut F3 and wrasse F1 generations and they have been through longterm programs that are now enhanced by modern techniques. The populations are all genotyped and maximizing genetic variation is the key objective The development of the halibut neo-male population has greatly short-circuited the breeding program. As for wrasse, we are only ten years into the program and hoping to identify the markers for growth, temperature
tolerance and robustness later this year as part of a program with the University of Stirling.
In the case of lumpfish, with a short generation time of two years, it has great potential to address some of the industry issues, such as the survival postdeployment, but it requires a long-term commitment from interested parties.

HFM: How do you manage to keep optimal environmental conditions for all these species?
AB: We are fortunate to have relatively good water quality from our primary source Loch Fyne. We use heat recovery in our systems where heat pumps are used as a source of heat for wrasse and chill for halibut, thereby splitting the heat of the 10°C water with 12°C going to wrasse and 8°C going to halibut.
HFM: Research and continuous innovation have been at the heart of Otter Ferry Seafish. What are the current projects you are working on?
AB: Previously, we have used spare production facilities for internal and commercial research. Last year, we invested in our own systems as well as a joint investment with AGR epi in MAIC Marine Aquaculture Innovation Centre. We now have facilities for the marine aquaculture sector and can now carry out commercial trials involving all species including salmon from larval rearing to harvest size.
HFM: Despite being difficult to make predictions, how do you see the future of Scottish aquaculture? How about hatchery technologies?
AB: Business is about predicting and managing change and strategy is about mitigating the threats and making the most of the opportunities. The biggest threat to the Scottish industry is climate change. In the past 50 years, the winter temperature of Loch Fyne has risen from an average of 5°C to 7.5°C, a 50% increase! In there, somewhere, may be an opportunity for the warmer spots around the UK coastline to revisit turbot, seabass and bream, amberjack, tuna, etc.
Hatchery technologies are well advanced and the lead time for tackling commercializing new species should be more appealing to funding agencies and investors. The marine resource around the UK is an extraordinary national asset that should be developed in a sustainable way for generations to come.
6
Hatchery
& Management Vol 10 Issue 4 2022
Feed
GenoMar opens state-ofthe-art breeding and genetics center in Brazil

Hendrix Genetics opens shrimp broodstock facility in Indonesia

Located on the island of Bali, the facility will be stocked with the same genetics as if a client bought directly from the Kona Bay operations in Hawaii, however, they will now receive a locally reared broodstock. It has a production capacity of 100,000 SPF vannamei broodstock per year. The company is establishing BMC operations in all the main shrimp markets. It is currently constructing a BMC in India, has a BMC in Malaysia and a hatchery operation in Ecuador.
The center located in Palmas, Tocantins will be the first of its kind for tilapia species in the Latin American region. It will have sufficient capacity to manage GenoMar’s breeding programs as well as produce parent stock for its distribution operations. The new facility will enhance GenoMar’s distribution infrastructure in Brazil and support its expansion efforts in the region with Colombia and Mexico in the spotlight.
Gold River Production acquires 100% stake of US shrimp genetics supplier
Gold River Production has acquired Texas-based company Trans American Aquaculture. Based in Rio Hondo, Texas, the company’s facility produces broodstock and post larvae shrimp for its own shrimp production and sale to other aquaculture companies including companies featuring RAS. By controlling its own “proprietary” genetic lines, the company can produce lineages with superior and sustained growth rates that are cold water tolerant and disease resistant.

Hatchery Feed & Management Vol 10 Issue 4 2022 7 HATCHERY FEED & MANAGEMENT NEWS REVIEW Highlights of recent news from Hatcheryfm.com News as it happens in the Newsroom at Hatcheryfm.com - SIGN UP FOR OUR FREE WEEKLY NEWSLETTER for updates
American Mariculture to distribute CP Foods’ shrimp broodstock worldwide
BluGen to deliver precisionbred olive flounder juveniles in the South Korean market
BluGen, a South Korean genomics and precisionbreeding aquaculture company, will be commercializing its precision-bred olive flounder (aka hirame) broodstock by building and operating South Korea’s first RAS facility. The RAS facility will include a hatchery and nursery with a production capacity of up to 80 million juveniles per year, and grow-out raceways with a production capacity of 1,000 metric tons per year. Production is expected to begin in Q4 2023.

CP Foods’ subsidiary, Homegrown Shrimp USA, has signed an agreement with American Mariculture (AMI) to distribute Homegrown’s selected shrimp. Shrimp will be marketed by American Broodstock Corp., a subsidiary of AMI, and will be shipped from its facilities in Florida to select markets around the world.

INVE Aquaculture to set up a hatchery technology center in Singapore

INVE Aquaculture and the Singapore Food Agency (SFA) signed an MoU to jointly set up SFA-INE Hatchery Technology Centre at SFA’s Marine Aquaculture Centre (MAC). The proposed center will bring together SFA’s expertise in hatchery design and production for tropical marine species, as well as INVE’s knowledge of specialized fish nutrition for early developmental stages. SFA and INVE scientists will jointly research to develop advanced hatchery technologies. The center will also serve as a training hub for farmers from Singapore and the region for knowledge transfer.
Cargill to increase shrimp feed production capacity in Ecuador
Cargill together with its partner Naturisa S.A. have reached an agreement to partner with Skyvest EC Holding S.A. to create a new joint venture that will serve Ecuadorian shrimp farmers’ increasing demand for high-quality shrimp feed. Through this
new joint venture with Skyvest, Cargill will expand its shrimp feed production capabilities to own and operate the shrimp feed production facility currently owned by Skyvest subsidiary Empagran, located in Guayaquil, Ecuador.
8
Hatchery Feed & Management Vol 10 Issue 4 2022
Hanna Instruments introduces monitor for marine aquaculture facilities
The company unveiled a new Marine Monitor for both the saltwater aquarium and marine aquaculture markets. This vertical mount unit can be used to continuously monitor pH, salinity, and temperature in tanks and systems. Users can get quick-at-a-glance readings and be alerted when measurements are out of range.

Skretting opens research station in Ecuador and fish feed factory in Vietnam
Luminis expands microbiome analytics to deep insights into probiotics and biofilters

Luminis’ Next Generation Sequencing (NGS) workflows have recently been expanded to shed light on water health: the beneficial bacteria. Fish and shrimp farmers can now test their water and get a complete list of all the probiotic or ‘biofilter’ species present along with abundances, which gives direct feedback on which probiotics and biofilters are working and which ones are not, saving both time and resources.
German supplier develops fish feeding system


The company opened its Aquaculture Innovation (AI) Guayas Research Station in Guayaquil, Ecuador. The station will study all stages of shrimp production, from larvae to harvest-size animals. The research will include health and welfare topics, as well as growth and feed efficiency. Skretting also opened its second fish feed factory, Lotus II, in Long An province, Vietnam. The facility features an ultra-fine grinding system that increases the nutritional uniformity in each pellet, increasing the absorption of nutrients by the fish and allowing the factory to produce special products with small sizes.
WEDA has developed a new feeding system that ensures optimal feed intake by optimizing the feeding times in fish farms. The new automated feeding system dispenses the feed evenly over 24 hours in fish tanks and ensures a balanced feed intake by optimizing the feeding times. The pellets remain intact which saves energy and improves fish feeding. The integrated computer program ‘Excellent Fish’ automatically weighs the exact amount of feed required and then doses and controls the speed of the dosing screws.
Hatchery Feed & Management Vol 10 Issue 4 2022 9
The importance of pump management in aquaculture
A recent report found that fish is the most traded food commodity. In 2021, aquaculture fish production reached around 90 million tonnes. The practice of farming aquatic fish, mollusks and crustaceans aims to stretch the production of these commodities. But could you afford to lose significant amounts of such valuable stock through bacterial infections of your farmed fish?
Diseases pose a major threat to these aquaculture environments with fish sometimes living in suboptimal conditions where overcrowding and low oxygen levels may threaten the crop. Insufficient monitoring of such diseases and existing aquaculture conditions increases the risk of disease.
By correctly using suitable chemicals in fish farms, the risk of disease can be lowered, but it is critically important that this is handled with care in order to maintain fish health. At Verder, we have specific ranges of pumps available to take the guesswork out of dosing these chemicals into your farm, with different functions to enable monitoring.
The Verderflex Vantage 5000 combines precision dosing and dispensing accuracy with high discharge pressures, an intuitive touchscreen interface and a USB backup port. Up to 30 dosing tasks can be programmed at once, allowing different amounts of chemicals to be dosed into pens depending on the needs of each particular net. As an added benefit, this pump can be provided with FDAcertified tubing where required, meaning compliance is ensured. As standard practice, the Vantage 5000 boasts tube burst detection and alarms, which alert the reader to any tube breakdown before it becomes an issue in the pumping process. Wireless connectivity allows remote control of your pump via Wi-Fi, providing real-time data for real-time actions. The system collects data for trend analysis and system performance improvements.
Creating cleaner environments through better prevention strategies can reduce the strains on the wellbeing of fish, leading to a better all-around stock. More information at www.verderliquids.co.uk.

PRODUCT FOCUS Hatchery Feed & Management Vol 10 Issue 4 2022
Hatchery industry outlook 2023

The start of 2023 could remain challenging for aquaculture farmers while coping with high input costs and what is likely to be a weaker demand. These issues directly affect hatcheries that need to adapt their production to demand and costs. Hatchery Feed & Management talked with industry stakeholders to have a look at the year ahead.
Rising production costs
Feed, labor and power are the main costs affecting farmers but it has not affected all farmers in the same way.
“During 2022, we have seen that inflation is impacting farmers differently depending on which market you look at. For example, Brazil and Vietnam were severely impacted because the rise in costs has been high and farmers were not able to pass the increased cost to buyers. This has caused an erosion of margins and a contraction of the overall demand for fingerlings and juveniles. In other markets such as the Philippines or Malaysia, the cost production pressure has been lower either because inflation has been somehow lower than
in other countries or because farmers have been able to increase prices,” said Alejandro Tola Alvarez, CEO of GenoMar Genetics Group.
How is the context affecting hatcheries?
In the case of shrimp, “the overall slow down on stocking of PLs by small and mid-sized farmers is directly affecting hatcheries now, but exporters and processors still need to cover their demands, so the industry maintains a significant momentum,” said Oscar Hennig, operations director of Benchmark Genetics Shrimp. In tilapia, “smaller hatcheries might try to save money by using lower-cost/quality feeds or eliminating the use of additives, such as probiotics, or environmental
Hatchery Feed & Management Vol 10 Issue 4 2022
OUTLOOK 2023
Credits: GenoMar Genetics Group
Credits: GenoMar Genetics Group
solutions, etc. That’s why is important to acquire fingerlings from professional hatcheries,” Hideyoshi Segovia Uno, general manager at Spring Genetics said. Hatcheries’ biggest dilemma is whether to produce or not given the uncertainty in markets, so farmers are not stocking or delaying stocking, David Danson, director of operations and shrimp, Hendrix Genetics, explained. He highlighted differences between species. “In salmon, and for large rainbow trout, hatcheries have continued to produce as products hatched today will lead to fillets in 1.5 to 2.5 years from now. Demand for pansized trout has remained stable, as this is a relatively affordable source of protein already. Shrimp has been most volatile, due to the combination of relatively short production cycles of 3-4 months and being a higher priced or more luxury product for the consumer,” Danson stated.
“For Norwegian farmers, the new tax system to be implemented in January 23 is also extremely high on the agenda as this will impact the operations and CAPEX going forward. Several projects are currently on hold,” Benchmark Genetics said.
And how the hatcheries have been soaring in this context? “The mitigation measures at hatcheries have been price increases to mitigate rising costs, efficiency improvement and cost reduction measures, and if demand becomes too erratic or volatile, shut down production temporarily to avoid destruction of stocks.
It’s a fight for survival in some sectors,” Danson stated. case of salmon hatcheries, “both integrated and independent companies, have focused on high egg quality – size, hatching rates, low deformities and high survival – and for fry and smolt on high survival, low size variation, synchronized smoltification and fast growth,” Benchmark Genetics said.

What to expect in 2023
levels are expected to stay, according to Segovia Uno. “In the case of exporters, the strong dollar their favor. We believe this situation might producers to prioritize better-performing ptimize their efficiencies.”
have tough times ahead in aquaculture, continue to dominate 2023 in all areas chain. As a breeding company, we believe farmers can give themselves the best opportunity to succeed by making sure they break with this downward spiral. This means getting stability in the supply chain (secure your partners, in feed, genetics, animal health and distribution), pushing innovation in the whole supply chain (disruptions like these also offer an opportunity for breakthrough), and specifically as a breeding company, making sure you cash on the generational improvement of your stocks,” Danson said.
“We expect that the inflationary pressure on production costs will stabilize during 2023,” Tola Alvarez said. “The biggest challenge in the long term is access to labor. We think this will continue to deteriorate in years to come. Tilapia hatcheries are typically located in remote locations and are very labordemanding and young people are less interested in working in the sector. We need to develop innovative strategies to attract and retain people.”
Feeds
With feeds being animal farming’s biggest cost, what are the mitigation measures farmers can adopt to reduce the impact of inflation? Stakeholders suggest increasing feed efficiency.
“Farmers are struggling with the increasing production costs, especially on feeds. This affects their investment capacity for growth and impels them to push efficiencies to the max. Farmers are trying alternate feed sources – some explore high-efficiency feeds, which are costefficient in the mid to long run, and some others could
12
Hatchery Feed & Management Vol 10 Issue 4 2022
Credits: Jennifer Doherty, Zeigler Bros. Inc. try and go for more rustic/basic and cheap solutions, which could affect their production results,” said Segovia Uno.
“As costs come under pressure, the major determinants of cost – feed and efficiency – become increasingly important. So, traits that affect feed efficiency, biomass and yield receive more focus because these are closely related to the cost of production and value of the final product,” said Alan Tinch, vice president of Genetics at the Center for Aquaculture Technologies.
“In times of high ingredient prices, it becomes even more important for the farmer to minimize the amount of feed that goes to waste, both the uneaten feed and the undigested feed – the latter has both direct and indirect cost. More efficient diets not only yield lower FCRs but they reduce the requirement for aeration, water treatment, etc.,” explained Mark Rowel Napulan, Asia sales manager at Zeigler.
“Sourcing highly digestible ingredients and incorporating them into a balanced formulation is the key. In recent commercial trials in shrimp hatcheries, we have reduced feed inputs by as much as 44% versus competing products. That means the customer pays less for feed and achieves a much more stable culture environment. Minimizing our investment in undigestible
proteins, our customers achieve better profitability,” Napulan explained.
What other measures hatcheries can adopt?

Optimization of processes and cost efficiencies in production, good quality genetics and good decision-making are key for success in the current state of the industry, according to Hennig.
Farmers can also intensify production. “Economies of scale approach have proven to reduce the overall cost per unit produced in many aquatic species. However, it must be coupled with knowing the market demand so harvest will be at the right time,” Napulan said.
Genetic programs can also benefit when production costs are rising. “When your fish grow faster your overheads are reduced, or you can choose to sell a larger product at a higher price. But we think that’s just the start. Many forward-thinking farmers and feed producers are starting to recognize the potential of genetics to breed fish that are selected specifically to require less food or even fish that thrive on lowercost feeds,” said Chris Wallard, chief marketing and communications at Xelect.
“In the current situation, with a focus on the shortterm cost of production, attention will focus on those traits most closely related to efficiency – growth and FCR. Growth is a major emphasis of most breeding programs, is easily measured and is highly correlated with feed efficiency. Other characteristics, such as edible yield and fat content, are increasingly considered as means of improving efficiency. All of these traits can be improved by using genomic selection, where genotyping is used to increase the accuracy of prediction in selecting broodstock,” Tinch said.
New technologies, such as automation and data analytics, are also other solutions for farmers to reach significant improvements in survival or food conversion. Find more inputs here.
Hatchery Feed & Management Vol 10 Issue 4 2022 13
Start strong, stay strong
Antonio Villanueva, BioMar
Novel microdiets and well adapted zootechnics bring the production of marine fish larvae closer to completely eliminating dependency on live feed.
The successful culture of marine fish larvae continues today relying on the use of live feeds. Significant advances in zootechnics as well as in the formulation and manufacturing of next-generation compound microdiets have been made in recent years. These developments allow for significant reductions in the quantities of live prey needed to produce juvenile fish. And more importantly, they allow for significant improvements in production consistency and juvenile quality, giving the larvae the best chances for a strong start to stay strong throughout the ongrowing stages. Novel microdiets are nutritionally richer, work well in automatic feeders in humid environments, are stable in the water and they are highly digestible. However, only together with well-adapted zootechnics will they get the sector closer to the “Holy Grail” of completely eliminating the dependency on live feed for the production of marine fish larvae.
Unique microdiets for unique hatcheries
“Each hatchery is unique, with a unique physical setup, tanks or light systems, unique water quality and water treatment systems, a unique set of environmental parameters, temperature profile, oxygen or CO2 levels,” explains Antonio Villanueva, BioFarm advisor in BioMar. His job consists in providing technical support to marine fish hatcheries, enabling him to monitor the diversity of farm management practices. Most importantly each hatchery has a unique technical team, where each person with a specific skill set complements every other member of the team’s abilities to reach the final goal of successfully producing marine fish larvae. Additionally, each microdiet is unique. It is the unique result of the interaction of two key elements: formulation and manufacturing process. Formulation ensures that the microdiet includes adequate quantities of the necessary nutrients in a balanced way. Moreover,
formulation is important for the physical properties of the particle and the manufacturing process.
The manufacturing process will mostly influence the physical characteristics of the microparticles, water stability or sinking speed, for instance. It will also influence the nutritional properties of the finished product by affecting digestibility or leaching in water. Both formulation and manufacturing processes will interact to produce a unique microparticle that will make nutrients available once it has been ingested by the larvae.
Feed and feeding need to go hand in hand
For the best potential results in any hatchery, using the best microdiet on the market will not be enough. Feed and feeding need to go hand-in-hand and need to be managed professionally. Standardized procedures and operational protocols need to be well adapted to the technical characteristics of the facility, as well as to the physical behavior of the feed that is being used.
The best feed can give suboptimal results if management is not well adapted to the use of that feed in that hatchery. Similarly, a suboptimal feed can give decent results with well-adapted management for that specific hatchery. The full potential of the farm will only be achieved by using the optimal feed with welladapted feeding and husbandry management for the hatchery in question.
The LARVIVA approach
BioMar prides itself not only on commercializing topquality feeds for hatcheries but also on being a fish microdiet manufacturer that has a comprehensive understanding of how to use its feeds in reallife conditions.
For real-life testing of its diets, BioMar has partnered with Hatchery Matters, a company specialized in
FEEDS Hatchery Feed & Management Vol 10 Issue 4 2022
developing elements, equipment and concepts for hatchery production processes, with a focus on standardizing processes, and increasing efficiency and quality of work. The collaboration with Hatchery Matters has resulted in the development of trials using the highest standards that can be found in the industry today. It has allowed for a deep understanding of the use of the products and for identifying opportunities for product development.
Monitoring feed intake
One of the most important aspects of marine fish larval rearing is related to monitoring feed intake, especially at feed transitions. Depending on the species, in the first 30 days of culture, fish larvae will typically eat three different types of feed (rotifers, Artemia and microdiet) of 5-6 different sizes (rotifers, nauplii, metanauplii, size 1 microdiet, size 2 microdiet, etc).

For a 5-milligram larva that grows 15% of its body weight per day, the ability to quickly adapt to a new feed type or new feed size can mean the difference between life and death. The lack of an adequate amount of daily feed intake can, for instance, have substantial consequences on bone calcification and deformity. Monitoring feed transitions in this phase is as crucial as the daily routine of monitoring oxygen in the tanks.
Gut content monitoring
Gut content monitoring is at the core of the work carried out with Hatchery Matters in the larval trials based on what BioMar calls “The LARVIVA approach” in which gut content monitoring is being used, step by step, to finetune the feeding process to ensure good feed acceptability throughout the whole larval rearing and especially at feed transitions (Fig. 2).
LARVIVA: A holistic approach to feed knowledge

The continuous effort on gathering knowledge to understand LARVIVA feeds starts in BioMar’s R&D department. At product conception and development, extensive laboratory and larval tests are used to provide valuable input to the development of new formulas and process technologies. The selected “pilot feeds” move one step up in the product development timeline, where our R&D department - in collaboration with BioFarm, BioMar’s technical support service - design and execute Protocol Development Trials (PDTs) where
the feeds are tested under different rearing protocols and for different species (Fig. 3, 4).
PDTs generate an enormous amount of information and serve several purposes. “We test the feeds by using different feeding protocols with varying live feed quantities, times of introduction of dry diets, feeding speeds, weaning ages and other conditions. These trials allow us to understand the limits of our products (minimum quantities of live feed, for
Hatchery Feed & Management Vol 10 Issue 4 2022 15
Figure 2. Gut content monitoring of seabass along with a scoring system - from 0 (empty) to 3 (full) - to assess Artemia (“art”) and BioMar microdiet LARVIVA ProStart (“PS”) repletion rate. Note that when microdiet uptake is effective, there is no difficulty in differentiating microdiet from Artemia.
Figure 1. Schematics of the process of gathering LARVIVA Feed Knowledge, by which information on nutrition, formulation, manufacturing process technology, quality control, feed usability and biological performance are combined to provide valuable input to product development and customer support.
instance) and to find the optimal protocols to use when benchmarking the performance of our feeds against industry standards. Additionally, we gain valuable knowledge to adapt the use of these feeds to different conditions in different hatcheries.

This knowledge is invaluable when providing our customers with support in the use of our feeds,” Villanueva informs.
Generating knowledge on LARVIVA feeds is an ongoing process. It continues in trials where the performance

16
Figure 3. Percentage of survival and deformity of 4 groups of seabass larvae (3-tank replicates) reared under four different protocols as an example of a Protocol Development Trial result. P1: Minimum use of Artemia nauplii, no metanauplii; P2: Minimum use of Artemia; P3: Low use of Artemia; P4: Standard use of Artemia.
Hatchery Feed & Management Vol 10 Issue 4 2022
Figure 4. A comparison of flowability vs. particle size for different feeds in the market witnesses of a good performance of BioMar’s LARVIVA ProStart. The lower the value on the vertical axis (y axis) the more flowable is the feed.
of BioMar feeds is continually benchmarked against industry-standard products for different species.
Antonio Villanueva explains the trials. “Thanks to our collaboration with Alberto García López, Hatchery Matters Manager, and his strong team, all of these benchmark trials are carried out on a pilot scale, following the highest industry standards and protocols and under very controlled conditions. All these efforts result in a highly reliable generation of data to build up our larval knowledge base. After the successful completion of this step, our products are tested in reallife production conditions through close collaboration at our customers’ facilities. This is the last step of our product development before the product enters the commercial phase at full scale.”
Quality control plays a pivotal role
Throughout the product development phase, and even onto the commercialization phase, there is a continuous effort towards understanding the most relevant aspects that a microdiet must have. Water stability, leaching, sinking speed/water behavior, flowability in automatic feeders or swelling in water are as crucial to a larval diet as the nutritional value or the digestibility of the feed. In this effort, the LARVIVA quality control department plays a pivotal role, in identifying what parameters can provide the best information and develop quality control methodologies.
Every hatchery’s feeding partner
Antonio Villanueva takes pride in the outcome of the efforts towards more sustainable first-feeding practices. “The data generated throughout the whole process, from product conception throughout commercialization provides the fundamentals of our larval feed knowledge base, being invaluable for improving our products and supporting our customers with the use of our feeds. This is how we see our role; not simply as a feed supplier, but as every hatchery´s feeding partner.”
“Our fish hatchery customers are the world’s leading experts in the operation of

their larval culture units. Their expertise, along with the quality of our products and our experience in their use, is the perfect combination to maximize the success of hatchery operations, giving the larvae a strong start, which is the best assurance for a strong performance through ongrowing,” Antonio Villanueva summarizes.


More information:
Antonio Villanueva BioFarm advisor BioMar
E: antgo@biomar.com
www.biomar.com
Hatchery Feed & Management Vol 10 Issue 4 2022 17
STA R T ST R ONG. STAY ST R ONG.
LARVIVA is a complete range of hatchery feeds, specially developed to maximize the success of the hatchery operations by giving your larvae a strong start ensuring high quality, robust and performing fry for the grow out stages.
The art and science of broodstock feed
Thomas Raynaud, ADM Animal Nutrition
Focusing on the early life stages at the hatchery and nursery levels for fish and shrimp builds a solid foundation for aqua producers, as early nutrition plays an integral role in the overall life cycle. These fundamental, first feed stages are among the main inputs that have an immediate impact and long-term effects on fish and shrimp to grow to their late stages. Proper and precise nutrition during these early stages are essential for organ development, disease prevention and final quality at harvest.
The same feeding concepts can be applied to broodstock fish and shrimp where the mature animals are used widely in the aquaculture industry for breeding purposes. Proper broodstock feed with raw materials

and nutrients makes feed more efficient and is shown to improve the overall yield and quality of eggs. Raw materials and feed ingredients also play a role in mitigating fish and shrimp exposure to environmental stressors and pathogens. Artificial and controlled feeds offset the potential health risks of fresh food and reduce the chance of contaminating broodstock with harmful pathogens. This can be achieved by replacing fresh foods with selected raw materials and highquality ingredients, such as fishmeal, microalgae, spirulina, pea protein, wheat flour, soy lecithin, yeast autolysate and more.
To provide a quality nutritional solution specifically formulated to meet the dietary needs of fish and
FEEDS Hatchery Feed & Management Vol 10 Issue 4 2022
shrimp at the broodstock stage, ADM’s global BernAqua hatchery and nursery feed brand developed its Royal Spawn and Omega Spawn broodstock fish and shrimp feed ranges.
Feed for the mature fish and shrimp
One of the most important challenges in the larval culture and fry is to guarantee an excellent quality of life from an early age.
Royal Spawn for fish and shrimp is a high-quality supplementary maturation feed for shrimp and fish breeders that includes new marine ingredients with the addition of algae to support immune function. The broodstock feed also promotes an improved fatty acid profile with microalgae-derived products, paying special attention to astaxanthin, phospholipid and vitamin levels in the feed.
Alternatively, Omega Spawn offers a semi-moist maturation feed for fish broodstock that contains all the necessary ingredients. It is processed with cold extrusion technology to prevent the denaturation of essential nutrients. It can improve fecundity and egg quality in fish and shrimp, as well as reduce biosecurity risks by replacing fresh seafood supplementation.

Putting ingredients to work
Raw materials and nutrients within the Royal Spawn and Omega Spawn feed ranges focus on three main pillars: attractability, maturation and health.
First, the ingredients in Royal Spawn and Omega Spawn work to increase attractability, palatability and digestibility that support growth, stress tolerance and boost survival rates. Krill, for example, allows for high attractability and palatability, helping with the growth and overall maturation of farmed fish and shrimp. Additionally, squid and fishmeal are both high in protein and improve egg quality. They also provide excellent amino acid profiles and are rich in fatty acids, perfect

Hatchery Feed & Management Vol 10 Issue 4 2022 19
MONITOR, OPTIMIZE, MONITOR, OPTIMIZE, AND BENCHMARK
WITH INDUSTRY-LEADING AQUACULTURE SOLUTIONS


development and maturation.
Second, Royal and Omega Spawn feeds provide special nutrients to optimize maturation. For instance, proteins and amino acids are used to support the biosynthetic process, which is intensified during maturation and reproduction. Phospholipids are also essential for broodstock maturation and help mobilize and transport fatty acids from the liver to organs, as well as stimulate gonadal development and improve nauplii
equipped to enhance broodstock maturation and their bottom line.
More information:
Thomas Raynaud

Head of Product Management, Aquaculture Feed and Specialties

ADM Animal Nutrition
E: Thomas.raynaud@adm.com
Copyright © 2022 Merck & Co., Inc., Kenilworth, NJ, USA and its a liates. All rights reserved. US-AQP-220300003 Hatchery Feed & Management Vol 10 Issue 4 2022
Marine fish hatchery automation
Gidon Minkoff
Gidon Minkoff operates consulting services for the hatchery sector at Fish Hatchery Consulting. E: gminkoff@gmail.com

Javier Parra, javiparei@yahoo.com, and Matej Leskovec, workmatejl@gmail.com contributed to this article.
Automation is essential for alleviating and reducing repetitive daily routines. By releasing the hatchery workforce from repetitive tasks, they can dedicate more time to the evaluation of biological processes and dedicate more time to system maintenance. Automation of processes can add stability to the systems and consistency of the product.
In the larval rearing process, continual control of major environmental parameters, such as light and temperature, will enhance uniformity in growth and development rate between batches and enable a production protocol to be accurate and reproducible. Applying automated feed distribution systems releases technician time, improves consistency in feed delivery and enables feeding outside the normal working day.

Within the complex environment of a fish hatchery, automation of the water distribution is an essential component of the process of producing fish. Small-scale family-run hatcheries will apply reservoirs and gravity flow for reducing the need to constantly manage the scale hatcheries apply controlled automation to their water distribution system.
The mechanical systems work through a variety of sensors, such as those for water level, flow rates, temperature, pH and oxygen. The sensors relay the information to actuated valves, pumps, heaters and chillers to maintain the rearing environment within the parameters assigned by the production protocols. All this information is sent to a SCADA (Supervisory Control and Data Acquisition) that will graphically display the
Hatchery Feed & Management Vol 10 Issue 4 2022 COLUMN
current status, advise on failures, and allow for changing configurations through drop-down menus. Information is also stored and can be accessed for analyzing current and historical production data.
Managing water resources is an essential part of life and is supported by a global network of equipment producers and suppliers. Hatcheries can therefore choose from a range of sensors, and water management systems as well as suppliers, for automating and controlling the water delivery in the hatchery. A professional IT technician can pick and choose between the variety of available equipment and integrate them all into one system. However, automation for controlling the hatcheries’ biological material, such as the production of live feed and larval rearing, is not as straightforward. As we go through the production processes, we move from monoculture systems for algae rotifers and Artemia, to the mixed culture system (which receives algae rotifers and Artemia) of the larval environment. As such, automation becomes more complex and the demand from sensors more exacting. Algae production is probably the only process that can be fully automated. The physical parameters can be controlled with standard sensors such as those for pH and temperature. The growth of the cultures in cell numbers can be evaluated via spectrophotometers or particle counters. The cell count can then be applied for controlling production processes such as inflow of the media, illumination, rinsing as well as the harvesting rate of the culture. It is for this reason that algae production systems, such as photobioreactors, have been around for many years even before the IT revolution. For rotifer mass cultures, the control of the physical environment, such as temperature and oxygen, can be carried out through sensors. Feeding frequency and amount can be automated via dosing pumps connected to a programmable controller. At this point, the hatchery needs to decide if it wants to work with a continuous production system or a semi-continuous batch culture system. For a continuous system, through defining water input/output and feed rate, the rotifer population will reach a steady state providing a constant daily output that is collected as feed for the larvae. The steady-state and amount harvested daily can be altered by changing the major input parameters. For a semi-continuous batch system, the amount of rotifers in a population determines the feeding rate. Therefore,
a regular count of the rotifer population is required as input into the computer that controls the pumps metering the feed.
It is with respect to population count input that we are missing one central piece of equipment, which is an automated rotifer counting system. A sensor, probably optical, that could count rotifers as well as eggs, work out the egg-to-female ratio and through that the general health of the culture would go a long way to resolving this shortcoming. This will release technicians from the constant need to count the cultures, the enrichments and quantities of rotifers provided to the larval rearing section. An automated counting system could also be applied for following the Artemia production from hatching through enrichment to feeding the larvae.
Much in the same way as the rotifer production, the delivery of live feed to the larval rearing tanks can also be automated with metering pumps and programmable controllers. With current technology, live feed quantities and distribution intervals can be programmed by applying charts and tables developed through production protocols. As far as I am aware, there are no in situ sensors capable of relaying to a programmable controller the real-time status of feed concentration in the larval tanks. In the absence of such sensors, throughout the larval rearing stage, regular input from manual observations is required for maintaining the desired live feed concentration relative to the rate at which the feed is disappearing from the larval tanks. Developing a sensor, most likely optical, capable of obtaining and relaying such information to a processor will add another step on the way to fully automating larval rearing.

22
Hatchery Feed & Management Vol 10 Issue 4 2022
Information is everything. Collecting and analyzing information is fundamental to the progress in all walks of life and also plays an important role in the progress being made in marine fish hatcheries. Hatchery biologists are continuously retrieving information from the rearing systems relative to growth, development, survival, feeding responses and pathological events. Numerous observations are made daily for determining if feeding rate, light intensity, flow rate or any other of the rearing parameters might need adjusting to improve the outcome of the rearing process. Optical systems both in-tank and overhead could provide a variety of real-time information, such as food availability, larval behavior, and possibly even growth and survival. The information could then be applied to constant adjustments of the rearing environment, such as feeding rate and light intensity.
On-going analysis of growth and survival relative to feeding and environmental conditions contributes towards incremental improvements in production processes and production outcomes. As hatcheries are subjected to the principle of economies of scale, increasing productivity reduces the perfish cost of production (COP) and increases the profit margin. The current situation with data collection in hatcheries is that a significant amount of information is not converted to data or stored in the hatcheries’ computers. The input through observations carried out by a biologist while observing a larval rearing tank, and the corresponding decisions to change flow patterns, light conditions or feeding rates are normally not registered. As a result, a significant amount of data that can be used for analyzing production success is lost.

The absence of data is therefore slowing down the rate of progress, reducing our ability to apply intelligent automation to our production systems. Developing the appropriate sensors will create an avenue for analyzing the flow of information from the larval tanks in relation to growth, development and survival accelerating the rate at which hatcheries improve the production process.

Hatchery Feed & Management Vol 10 Issue 4 2022 23
Water Conditioner
AquaMatrise
Mette Cristine Schou Frandsen,
Oxygen is considered the most important water quality parameter in fish farming. This, however, is not completely true. Oxygen is no more important than CO2, pH or other environmental variables, and any factor going out of the tolerance for the fish will either kill it or negatively affect its welfare and growth.

However, oxygen-in-water is a very fluctuating substance, and oxygen levels can change rapidly going from optimal to lethal in minutes. To ensure a safe production environment, it is essential to monitor and control oxygen levels in the water.
Several studies demonstrate a better digestibility of the feed at a high oxygen level – albeit within certain limits. The optimal feed conversion rate (FCR) is reached with oxygen levels of 80-120% saturation, depending on species, life stage, stock density and size of the fish.
Above and below levels will adversely affect FCR.
The simple answer to the above question is: YES, there is money to be saved by measuring and controlling oxygen levels in your fish farm.
Hints to get the most out of your oxygen measurements
Find out the optimal oxygen concentration for your stock and your species. You can include possible variations related to age/development, for an even higher degree of precision specific to your stock. Besides the optimization of the FCR, this will also make your growth prediction more accurate saving money and enable more precise planning of your production. This can make an impact to the bottom line. To give an example, Tsadik and Kutty (1987) showed how
Can you save money by measuring oxygen or by optimizing your oxygen measurement in aquaculture?
MONITORING
Hatchery Feed & Management Vol 10 Issue 4 2022
OxyGuard
SYSTEMS
food intake decreased by 40% for Nile tilapia when the oxygen content in the water was reduced from 7 mg/l to 1.5 mg/l. This is a dramatic reduction and an indication that big advancements can be done even by regulating the “last digits”.
Choosing the best oxygen sensor
If a manufacturer states that no maintenance is required, be very careful. All physical objects in water will experience biofouling. A good sensor is sensitive and will react to dirt and therefore need maintenance. You may have gotten the idea that optical probes are better than galvanic probes. This is not true. A good galvanic probe is better than a bad optical probe. The best galvanic probe is as good as the best optical probe. It’s all a matter of your needs.
Choose a sensor with good accuracy (minimum 1-2% saturation). This will ensure the quality of the sensor and provide reliable measurements. As stated above, all sensitive probes require maintenance. This is true for both optical and electrochemical probes. So, make sure to have a maintenance schedule in place.
Small farms
Manual observations are cheap and you can go through all your tanks/ponds using the same handheld probe.

This is a good choice for farmers with few ponds/ tanks and a good schedule to do the survey. Going from not measuring oxygen at all to even doing few measures during the day can enable you to do extensive improvements, and savings. It can tell you when oxygenation is most needed and when it is of lesser importance. Begin your measuring regimen by doing measures early in the morning – this will tell you if your stock experiences hypoxia during the night time due to phytoplankton respiration causing the oxygen levels to drop. Next measurements should be before feeding and, for example, an hour after feeding to see how much oxygen is needed during feeding. Based on these simple data points, you can already optimize when to turn on paddle wheels or other means of aeration/ oxygenation or delay feeding until oxygen levels are within safe levels.
The disadvantage of this procedure is the lack of continuous measurements giving rise to potentially dangerous situations where low oxygen is not registered and handled. For some species, this may be temporarily harmless, but it will significantly lower production or extend the production period, both very costly. For other species, it can be very harmful and mass die-offs are seen regularly. Using a manual probe will give you a rough idea of the oxygen content in the water, but the degree of details in the diurnal oxygen measurements can make it hard to do targeted improvement. It is possible to buy a relatively small monitoring system such as a “Pondmaster” that can be programmed to activate aeration before feeding and provide alarms when oxygen levels are out of range. In many cases, this is advantageous for even small fish farms.
Medium facilities
The next step to ensure even bigger savings is introducing an online monitoring and control system using stationary sensors such as the “Pacific” system. A simple system like this comes with full monitoring 24/7 and an inherent alarm system that will alert you in case there is low oxygen content in the water. This enables you to do a full assessment of the oxygen need and consumption on your farm. Very often such systems offer to start redundant systems for oxygenation/ aeration or even start an emergency generator in case of power failure.
Hatchery Feed & Management Vol 10 Issue 4 2022 25
Large facilities and RAS

The relative savings with data-driven control often surpasses the expenses associated with the investment. The sector saw significant improvements in production yield with the introduction of monitoring and control systems, but there are still many possibilities to improve even more. The water quality data, and correlations with other important datasets in your farm from pumps, filters, UV, ozone and feeding systems are often far too complex to comprehend. Often, accessibility to skilled personnel is also a challenge. With the introduction of digital platforms and artificial intelligence, it is possible to go to full length with optimization. This is still fairly new and under constant improvement – we have only seen the very beginning of the future of digital fish farming. Accessing a digital platform is an absolute necessity for large facilities and RAS. It is a matter of time before farms without digitalization will lose the competition to digitalized farms. It is recommended to start digitalization process now. A future complete transition is hard and it is easier to be part of a co-creation process.
Take care of your data. Many providers of digital solutions claims ownership of your data once transferred. Claim ownership of your data by choosing a platform that gives you sole ownership and allows you to decide who, and to what extent, others should be given access, e.g., Cobália. It is difficult to switch digital platforms after deployment, so be careful when choosing. Quick benefits now may not be beneficial in the long run. Ensure a platform able to work with whatever brand of data-collection equipment you might want to use in the future.
More information:
Mette Cristine Schou Frandsen Communication Adviser OxyGuard E: mf@oxygaurd.dk

26
Hatchery Feed & Management Vol 10 Issue 4 2022
Turbidity: An invaluable tool for understanding farm performance
RAS farms generate enormous amounts of fine particles. These particles can have multiple origins, such as feed, feces, biofilm release or from various other sources in the system. High concentrations of particles have been proven to have direct adverse effects on fish stress levels, growth, disease resistance, and gills. The effects are, however, not limited to the fish but are also detrimental to both biofilter and degasser performance. High levels of fine particles increase heterotrophic bacterial growth, which in turn can reduce TAN removal in the biofilter, raise oxygen consumption and increase CO2 production. Trapping and sudden release of fine particles can have very serious negative impacts on water quality, which often is associated with large fish mortality.

Therefore, it is important to measure particles in the water and monitor the levels of particles throughout the production phase. There are different ways to monitor particles in the water, each with its strengths, and often hard to directly compare against each other. Turbidity is the optical property of water where both dissolved and suspended materials can influence the scattering of light in the sample.
Turbidity has historically been used in field studies due to the relative ease of measurement as well as the relative relationship with total suspended solids.
How?
Turbidity can be measured with a centralized sensor cabinet with many sensors, such as specialized turbidity measurement under pressure, that monitors the on-site water quality from up to 12 places. This means the water samples are sent to the sensor by decentralized pumps, delivering from strategic locations across the RAS farm in the same manner as a worker would sample those places manually.
Using a single sensor means all measures can be directly compared against each other without sensor error interference. This makes it possible to calculate changes across various devices in a RAS, which can be called gradients. By applying gradients, advanced alarms can be provided for an early warning against a poorly functioning water treatment device on a RAS farm.
Due to the replicability of the solution, benchmarks for gradients and water quality changes can be calculated and presented for all clients around the world. This is done via an intricate anonymization of the data, so no information is shared between the individual clients but still indicates individual performance via an online visualization platform. One of the more important benchmarks to follow is the turbidity gradient across all devices, such as fish tanks on the farm.
Hatchery Feed & Management Vol 10 Issue 4 2022
MONITORING SYSTEMS
Caspar Yan Hansen, David Owen, Blue Unit AS
Turbidity gradients on a malfunctioning fish tank
If a fish tank is not efficiently removing particles, then data indicates that the other devices of water treatment do not function correctly. A malfunctioning fish tank will cause poor drum filter performance followed by heavy particle trapping either inside the biofilter or degasser. Particle build-up can result in tragic results, including the establishment of pathogens, hydrogen sulfide release or, as in the following example, a loss of fish appetite and bacterial infections.
But how did poorer self-cleaning by the fish tanks impact the rest of the RAS farm? A mass balance that determines how much turbidity was shifted by each device per day clearly indicates the effect.
The top graph in Figure 1 shows the turbidity time series for the RAS farm. In Period 1, a stable turbidity
level persisted, until the grey bar (fish tank performance alert). Thereafter, turbidity rapidly increased – Period 2.

The mass balance for Period 2 saw 0.33 NTU turbidity passing across the fish tank per day (Fig. 1 a, red box). This is more than twice the 0.13 NTUs of turbidity passing across the fish tank in a day in the period before the alert (Fig. 1 a, blue box).
Drum filter performance also reduced from removing -0.08 NTUs in Period 1 to removing -0.05 NTUs in Period 2 (Fig. 1, b). The biofilter also began to lose particles following the change in fish tank performance (Fig. 1, c).
From the overall pattern, the change in fish tank performance meant particles stayed longer within the fish tank, creating additional fine colloids that pass more readily through the water treatment devices, contributing to a general increase in system turbidity.
28
Hatchery Feed & Management Vol 10 Issue 4 2022
Figure 1. The upper graph shows turbidity (NTU) as a function of time (days) with a grey indicator bar at the inflection date.
Summary
Monitoring gradients around RAS farms is one of the most useful tools to manage the overall fish farm water quality. A malfunctioning device, such as a fish tank, will create issues for other parts of the RAS farm. Data indicates that turbidity issues will also be often associated with detrimental values for many other water quality parameters and finding the root cause for bad water quality or poor fish health can be hard to locate without heavy use of labor hours or a centralized solution that gathers enough data to confidently locate the issue.
By measuring in a centralized fashion, a fish farm manager can identify where turbidity is being created and removed. A fully automated system that continuously monitors and uses data for modeling allows fish farmers to react more efficiently as compared to older management approaches. Without the data then the farmers are destined to act based on limited intel without having the data to back up their decisions that could enable them to act with precision. An internal analysis showed that after the installation of centralized monitoring equipment with online 24/7 visualization, all monitored fish tanks saw a reduction in turbidity. This in turn was accompanied by a reduction in CO2 level in 33 out of 36 fish tanks. Thus, underlining

that many seemingly well-performing fish farms still have room for serious improvements in the functioning of their water treatment systems. Moving towards using gradients and a holistic farm health view, a higher yield can be accomplished, while still maintaining a high degree of fish health.
More information:
Caspar Yan Hansen
Data
& Analytics consultant
Blue Unit AS
E: cyh@blue-unit.com
David Owen Technical Manager Blue Unit AS


E:
dowen@blue-unit.com
Hatchery Feed & Management Vol 10 Issue 4 2022 29
Figure 2. One view of the online data visualization from Blue Unit.
“Don’t count your chickens…”
Tony Broadhurst
 Technical advisor for Aquafoods.
E: anthonypaulbroadhurstfish@hotmail.com
Technical advisor for Aquafoods.
E: anthonypaulbroadhurstfish@hotmail.com
Compared with other livestock managers, those of us who spend our lives breeding marine fish are in a somewhat unusual situation. I can think of no other sector where one manages animals with such high rates of fecundity. When this fecundity is associated with high rates of fertilization, hatching and early survival that are now common in aquaculture (maybe some who work in other sectors would take issue over the last), it is not implausible for a single female fish in our hatcheries to spawn sufficient eggs to produce more than a hundred thousand juveniles each year. Compare this with the same individual in the wild, where one imagines it would be unusual for more than a few of her offspring to survive until maturity during her entire life.
Not all species behave the same way, of course, but many of those that I have come across seem to fit this profile. For example, a 4kg turbot (Scophthalmus maximus) female may ovulate several times in a season, yielding more than 10% of her weight in eggs (each weighing 1mg) per ovulation. A 1½kg gilthead bream (Sparus aurata) might yield more than twice her weight in eggs per spawning season (eggs about 0.9mg each.) Though a similar-sized female snapper (Lutjanus guttatus) will not ovulate the same biomass over such a short season, she probably will produce a similar number of eggs over a year as her eggs are much smaller and she will spawn over a longer period.
Given the high cost of developing any species for aquaculture, there has been an understandable tendency to avoid spending more money on broodstocks than appears to be necessary at the outset.

Recruitment to the original broodstock is usually limited to just a few dozen wild-sourced individuals, and there are always strong short-term economic incentives to renew stocks using the offspring of these. This is often
where the “rot” sets in since it is very easy to lose much of the genetic diversity that exists within the wild-type captive population in the first (“F1”) generation – later generations may lose even more.
The main causes of this are two-fold. First, it is highly unlikely that all the potential male/female parental combinations will occur in a population which is left to spawn spontaneously in captivity since certain males are often dominant over others when competing to court females and fertilize their eggs as soon as they are released.
COLUMN
Hatchery Feed & Management Vol 10 Issue 4 2022
Rose spotted snapper ( Lutjanus guttatus ) courting in daylight (from video still/Kevin Ruiz/Aquafoods)
Second, not all the eggs that are collected are given a chance to prosper. As production managers, we always try to keep essential bioresources available in excess, so we usually select which eggs to stock into our rearing systems on the bases of our needs, quality indicators during the incubation stage, and convenience. Since it is unlikely that all fertile females in a broodstock will release their eggs simultaneously, by failing to stock a cocktail of fertilized eggs from each day’s spawn, we could be excluding certain females from contributing to the genetic pool of the F1 generation.
If we source our original parent stock from other hatcheries’ commercial output, it is highly likely that genetic diversity within this pool of individuals will also be compromised by the same mechanisms as described above.
Even in the cases of species that do not usually spawn spontaneously in captivity, there are risks to diversity. Here, we would appear to have a perfect opportunity to control the lineage. However, stock management of such broodstocks is highly labor-intensive since we often need to monitor females individually throughout their spawning season, both to predict their ovulatory cycles and strip out their eggs – males tend to receive far less consideration. The number of individuals under management in broodstocks of these species is usually kept low in order to save effort, which obviously limits the stock’s genetic diversity. If we add to this the possibility that some of the earlier generations might have stemmed from an even more limited number of “favorite” crosses, the likelihood of inbreeding within later generations increases dramatically.

Tracing back the lineage of individuals over decades of captive breeding is often a daunting task. Marking technology has improved greatly with the advent of PIT devices, and record keeping has been facilitated by access to computing technology. However, even since introducing these tools to our operations, many of us have remained less concerned about the genetic niceties of what we were doing than about simply achieving our annual production targets. Nowadays, we can measure the end results of our (mis)management using molecular techniques, but if these don’t look too promising, then we really have no alternative but to rejuvenate our broodstocks by recruiting more diverse specimens.
Meanwhile, I would recommend to anyone who is just starting out with the development of a new fish species for mariculture that they bear in mind the genetic implications of what they are doing, right from the outset. I realize that this advice sounds rather hollow, given some of the decisions that I have taken in this respect over the years. However, by accepting it, others might save themselves a lot of time, effort and money if they are planning to improve their product performance genetically in the future.
Let’s not get too carried away, though. While uncontrolled inbreeding is obviously something to be avoided, genetics will not solve all our problems. Despite recent evidence pointing towards mutations at discrete loci being associated with certain skeletal deformities of gilthead, I suspect that some aspects of our intensive hatchery environment still outweigh pure genetic effects with respect to the quality of most of the cultured marine fish species that we produce. Even growth performance – the most common trait chosen for improvement in genetic selection programs – can be affected by esoteric environmental influences, such as the bacterial microflorae and/or the digestibility of the live feeds used in intensive hatcheries during larval rearing – let us not forget that neither rotifers nor Artemia are the “natural” food of marine fish larvae. Without wishing to advocate for a return to extensive rearing methods, I do think it’s important that we stabilize our hatchery environment before embarking on a genetic selection program.
By now, I’m sure that some readers are wondering what all the above have to do with this column’s title. Well, very little, to be honest. However, in my previous
Hatchery Feed & Management Vol 10 Issue 4 2022 31
Semi-spontaneous egg release by an Atlantic halibut ( Hippoglossus hippoglossus )
effort, I raised the subject of the “cardinal sins of aquaculture” and proposed arrogance as the second of these. While I’m not sure if there are many more, I do believe that there’s at least one other besides this one. Returning to the title, I expect that most of you who were raised with English as a mother tongue will have received this admonishment at least once in your lives. The full phrase is “Don’t count your chickens before they’re hatched”. In my opinion, complacency is the first cardinal sin of aquaculture. While – in business – I realize that we need to project our future based upon a large mass of assumptions; when working with biotechnical systems I feel that the greatest danger lies in mentally allowing these assumptions to mutate spontaneously into facts. For example, we can build an annual production plan and budget around our expectations that the broodstocks will spawn, the rotifers will grow, and our site’s installations will not let us down. However, that does not necessarily mean that they will do so. More to the point, if we start to presume on the fact that they will, the chance that they will not seem to increase dramatically. Failure of any one of these components can foul up our plans quite royally, so I think it’s helpful to maintain a healthy sense of paranoia, just to keep us working hard enough to avoid a catastrophe. Mere paranoia is not the solution, of course. Rigorous monitoring, data analysis and maintenance are clearly the keys to keeping our systems running smoothly (unfortunately these all cost money) but there is also a superpower that can be used to help, and which is relatively cheap. Anybody can acquire it with a moderate amount of effort – indeed, many of you will have already done so – and I shall reveal it in my next column.
















32
TO LEARN MORE : ReedMariculture.com/most
Atlantic halibut eggs in a 100-mm diameter petri dish. These eggs are larger than those of any other cultivated marine fish.
Our expanding line of Instant Algae® microalgae includes 6 single species of algae and 9 blends.
Intact, whole-cell algae retains full nutritional value, no need to hydrate.
Biosecure, pathogen-free and clean.
© 2022 Reed Mariculture, Inc. All rights reserved. Instant Algae, Ensuring Hatchery Success are trademarks or registered trademarks of Reed Mariculture Inc ∙ 1 ∙ 2 ∙ 3 MOST
MICROALGAE Hatchery Feed & Management Vol 10 Issue 4 2022
Concentrated, easy to use, and always available.
COMPLETE SELECTION OF
Turning probiotic bacteria into an effective microbial management tool for shrimp aquaculture
 Barbara Hostins, Pranisa Suthianthong, Laurent Marien, Peter De Schryver, Inve Aquaculture (A Benchmark Company)
Barbara Hostins, Pranisa Suthianthong, Laurent Marien, Peter De Schryver, Inve Aquaculture (A Benchmark Company)
Among the strategies to obtain effective shrimp aquaculture methods, the application of probiotic bacteria has become a worldwide practice. First developed in the 1990s by Professor David Moriarty together with specialists from INVE Aquaculture, the concept of using probiotics is now backed by plenty of evidence that – when applied properly – it is an effective strategy for modern shrimp aquaculture. INVE Aquaculture continues to develop its probiotics solutions, such as the well-known Sanolife® range, into stable, easy-to-use, and cost-effective solutions with the highest number of active good bacteria per USD invested.
Clear and proven benefits
The benefits of probiotics have been elaborately observed and reported by scientists, industry experts and farm managers alike. The potential to actively modulate the animal’s gut microbiota and boost their immune response are qualities that turn probiotics into an essential part of aquaculture’s toolkit for microbial management. Probiotics also improve water quality conditions, reduce organic waste in the ponds, and optimize the shrimp’s feed utilization through the production of digestive enzymes (Hoseinifar et al., 2018, Jamal et al., 2019, Soltani et al., 2019). Finally, objective data show that probiotics contribute to improved growth and survival.
Identifying the most suitable species and strains
Many bacterial species have been investigated as potential probiotics. But commercially available products today mainly contain strains of the taxonomic orders Bacillales and Lactobacillales. Within these
orders, most aquaculture probiotics are found in the Bacillaceae and Lactobacillaceae families. The latter are classified as Lactic Acid Bacteria (LAB), named after their metabolic end product. They are traditionally used in food fermentation and became known for their health benefits since the beginning of the 20th century. Despite their numerous gut health benefits, Lactobacillus bacteria present significant challenges in terms of viability when used in food/feed matrices. The reason is that they are most often applied as active or freeze-dried live cells. Under challenging field conditions such as pH and temperature variations, adding live probiotics to the feed may cause their inactivation (Ouwenhand, 2013). For optimal efficacy, the bacteria would benefit from extra protection, added for instance through encapsulation techniques. But this would evidently increase the cost and complexity of the production process.
Hatchery Feed & Management Vol 10 Issue 4 2022
MICROBIAL MANAGEMENT
Figure 1. Structure of bacterial spore, from Tehri et al ., 2018.
Moving towards optimal (cost-)effectiveness
An obvious alternative is to use probiotic species that are naturally protected. Bacilli, for instance, possess the natural capacity to form highly resistant, metabolically dormant structures that are called spores. If looked at the structure of such a bacterial endospore, its core contains a condensed and inactive chromosome. This is surrounded by a peptidoglycan cortex, and one or more layers of protein material, known as the spore coat (Fig. 1 from Tehri et al., 2018) (Cutting, 2010).
The interesting thing about this spore coat is that it protects the organism against harsh conditions, such as UV radiation, free radical and enzyme activity, and temperatures up to 80-85°C (Nicholson et al., 2000). The intrinsic capability to form a protective spore coat makes Bacillus a relatively stable bacterium (Ouwenhand, 2013). Because they can survive longer under the influence of environmental stressors, endospore-forming bacteria show better viability than lactic acid bacteria during production and storage, and thus a more stable shelf life in dry food matrices.
Germination: Getting dormant bacteria to become active
What’s important to understand, though, is that the bacterial cell inside the spore coat is in a dormant state. To resume its probiotic activity, it needs to go through an activation and germination process. Depending on the strain type, the bacteria will respond to environmental parameters, such as water activity, temperature or nutrient levels. Step by step, the

spore coat layers become permeable. Eventually, they degrade completely, the bacterial cell leaves the membrane and resumes its metabolism. A good understanding and control of this process is crucial to effectively applying Bacillus probiotics to the shrimp pond water or in the feed.
Sanolife® Probiotics
What can probiotics manufacturers do to ensure the adequate revival of the Bacillus spores used in their products? As a leading example in the industry, INVE Aquaculture developed an assessment method for the spores used in its Sanolife® range. With real-time phase-contrast microscopic images, INVE documents the transition time from a non-germinated spore (phase bright) to a germinated spore (phase dark), and the consequent evolution into multiplying cells. Figure 2 illustrates the mounting of spores (i.e. the yellow circle) into a microscope chamber with growth media on a glass slide, monitoring the process.
Proven 96% germination
These microscopic analyses prove that spore germination of Sanolife® Probiotics occurs within 10 minutes after incubation when exposed to temperatures of 27-30°C. Within 1-2 hours, the spores grow into vegetative cells, and from 3 hours onward, cell replication begins (Fig. 3A, 3B). Arrows indicate individual spores demonstrating a transition from phase bright over phase dark to multiplying cells. The germination percentage reaches 96% in a little over 1 hour (Fig. 4).
34
Hatchery Feed & Management Vol 10 Issue 4 2022
Figure 2. Illustrative scheme of closed air-containing chamber slide used to track spore germination process in a phase-contrast microscope.
Translated to shrimp farm practices, this means that from the moment Sanolife® Probiotics are applied to the pond water (or reach the shrimp gut when added to the feed), 96% of the spores will germinate in less than 2 hours. Under lower temperatures (<20°C), the
spores take about 30 minutes to activate (Fig. 5), and around 3.5 hours to reach around 80% germination (Fig. 6). Hence, for low water temperature cultures (<20°C), it may be advisable to briefly activate the spores in warmer water before applying the probiotics.



Hatchery Feed & Management Vol 10 Issue 4 2022 35
Figure 4. Percentage (%) germination of Sanolife ® spores under 27-30°C in time-lapse series
A B
Figure 3. (A) Sanolife® Spore germination process from 0 to 50 minutes in time-lapse recording and closed air-containing chamber (incubation 27-30°C). Black arrows indicate the ongoing process tracked in individual spores. (B) Sanolife® Spore germination process from 1 to 6 hours in time-lapse recording and closed air-containing chamber (incubation 27-30°C). Black arrows indicate the ongoing process tracked in individual spores.
Comparative studies
Besides water quality parameters, the type and origin of the bacterial strains are essential to choosing a probiotic product. This is clearly illustrated by a microscopic comparison between INVE Sanolife® Probiotics and an alternative Bacillus-based product. After 4 hours of incubation under the same conditions, Sanolife® spores have germinated and grown into vegetative cells, while
most cells of the alternative Bacillus-based product are still in non-germinated spore form (Fig. 7).




INVE Aquaculture will continue its efforts to acquire in-depth knowledge of probiotic mechanisms, to deliver products with documented qualities and to provide farmers with hands-on information to obtain optimal results.
References available on request.
More information:
Barbara Hostins
R&D Group Leader

Health & Environment
INVE (A Benchmark Company)
E: b.hostins@inveaquaculture.com
36
Figure 5. Sanolife® Spore germination process from 0 to 9 hours in time-lapse recording and closed air-containing chamber (incubation <20°C). Black arrows indicate the ongoing process tracked in individual spores.
Figure 6. Percentage (%) germination of Sanolife ® spores under <20°C in time-lapse series
Figure 7. Comparison of germination process between Sanolife® spores and an alternative Bacillus-based product in 4-hour time.
Sanolife® 4h
Hatchery Feed & Management Vol 10 Issue 4 2022
Bacillus-based product 4h
Building robustness in the early stages of shrimp lifecycles
Louise Buttle, Benedict Standen, DSM Animal Nutrition and Health
The global population has reached eight billion and continues to grow exponentially. With this rapid growth, the demand for animal protein will continue to rise, placing enormous pressure on the planet’s finite marine resources.
Since 2014, the aquaculture industry has provided a large proportion of seafood processed by humans and is expected to account for approximately 60% of total consumption by 2023. Shrimp, pangasius, tilapia and salmon production alone accounts for 24% of global production making sustainable and productive approach to production key to reducing the overreliance on our finite marine resources.
The key to productivity is building robustness, ensuring maximal survival rates, growth and feed conversion. When it comes to survival, there are several ways producers can do this in the early stages of the lifecycle, while retaining a sustainable approach to farming. This includes pathogen inhibition and the regulation of environmental conditions to ensure optimum performance.
How to build a robust shrimp
Building robustness, particularly in the early lifecycle, is key to making production both economically and environmentally sustainable. When shrimp hatch,

Hatchery Feed & Management Vol 10 Issue 4 2022
MICROBIAL MANAGEMENT
their gut is relatively sterile which makes them very susceptible to opportunistic pathogens, making it important, at this early stage, to set up a healthy microbiota through probiotic supplementation.
A robust shrimp will grow faster, be less susceptible to disease and infection, and be better equipped to handle the transfer and environmental fluctuations. Disease compromises performance, yield, and product quality and generates a range of ancillary costs in terms of diagnostics, treatment, feed conversion, time, and labor as well as market reputation.
From the hatchery level, optimum vitamin nutrition (OVNTM), particularly vitamins C and E, plays an essential role in building robustness – strengthening the immune system and building resistance to stress – in turn, improving the health, performance, and longevity of the animal’s life.
DSM has developed feed additives, such as Rovimax® NX Plus , to specifically tackle the challenge of strengthening the immune system. It offers a range of benefits to nutrition, such as providing nucleotides that are essential for performance. Research has also found that adding optimal nucleotide levels to the diet can improve gut health and support the gill, hepatopancreas, spleen, and kidney function of marine life.
Inhibiting pathogen infection
Vibrio spp. is a pathogen found in a wide variety of aquatic and marine habitats and is a major part of the microbiota, even in healthy animals. However, certain Vibrios produce dangerous toxins that attack the hepatopancreas in shrimp, causing high mortality rates.
An additional threat to health is caused by biofilms – thin, resistant layers of bacteria. As such, finding a way to inhibit pathogen infection, and manage the
growth of Vibrio, is essential in ensuring the production of healthy shrimp.
This is where probiotics, such AquaStar®, which is capable of inhibiting a wide range of aquaculture pathogens, become an integral component of the value chain. By managing direct inhibition, toxin reduction and quorum quenching through leveraging the use of probiotics producers can directly impact the growth of pathogens and degrade toxins that attack gut and hepatopancreas tissues.
Improved environment
Shrimp share an intimate relationship with their environment, meaning they are continuously exposed to pathogens and toxic substances in pond water which can negatively impact overall health and performance.

As with most aqua species, artificial feed in shrimp ponds and high stocking densities may have detrimental effects on water quality through the accumulation of waste matter (uneaten feed) and black sludge at the bottom of ponds. The breakdown of organic compounds forms toxic metabolites, such as hydrogen sulfide, ammonia, and nitrite. Removing these compounds is a time-consuming and expensive procedure, but a vital step in ensuring the health of the animal.
The use of products like the probiotic solution AquaStar® can improve the hatchery environment by controlling organic matter and removing harmful metabolites. Improving water quality directly impacts productivity, improving the growth performance from hatchery to harvest, and can reduce production risk from pathogens and reduce time to market.
As the world’s fastest-growing animal protein sector, aquaculture has the potential to deliver enormous benefits in terms of production output, nutritional value, and financial returns. By building a robust shrimp in the initial stages of the lifecycle, producers are better equipped to improve survival rates, and manage harvest cycles and financial costs, ensuring the most sustainable approach to farming.
More information:
Benedict Standen
Head
Aqua Marketing Global
DSM Animal Nutrition and Health
E: benedict.standen@dsm.com

38
Hatchery Feed & Management Vol 10 Issue 4 2022
The unintended cost of water disinfection in RAS systems
Rachelle Jensen, Luminis Water Technologies
Disinfection is a standard water treatment that reduces the pathogen load before the grow-out begins. Effective treatment options include UV, ozone, and chlorine. They all work by degrading DNA non-selectively, which means the treatment kills off both good and bad microbes. Ozone, in particular, is very powerful.
Beneficial microbes that deliver essential services for water quality, like ammonia and nitrite reduction, are reduced or eliminated during disinfection. Probiotics are also degraded, which means losing huge benefits like immune support, stress relief, higher growth rates, and lower mortality in stock.
However, the most devasting aspect of water disinfection is the drastic reduction of the diversity and abundance of the overall microbial community, which forms the foundation of health in the aquatic setting.
Once the microbiome destabilizes, we lose the competitive pressure of other microbes that keep pathogens in check. And without any competition for space or resources, survivor pathogens are free to wreak havoc in a system, which they do.
Setting the stage for trouble ahead
There is an inherent balance between removing pathogens and preserving beneficial microbes that are required to support fish and shrimp during grow-out. To determine ozone’s effect on water and optimize the use of ozone, we looked at how the microbiome fares after a 12-hour ozone treatment (Fig. 1).
We took six samples overall; three consecutive days before the ozone treatment and three consecutive days after ozone. The three samples taken at days -3, -2, and -1 before ozone showed a solid baseline in the water as nature intended it: diverse and stable.
Even at the genus level, we can see that the community changes very little, with only a small drop in the population of Pseudomonas (a good thing),
and Candidatus Pelagibacter shifts a bit, but overall we would label this kind of movement as statistically irrelevant.
The three samples taken consecutive days after the ozone treatment shows a very different story. After the ozone application, we see dramatic shifts in the community due to the crash out of almost all the microbial species. At this point, there is a race for equilibrium to fill the newly created void. Over the next three days, we see wild swings in the rise and crash of various species, which shows that the water had not yet reached equilibrium by the end of our study.
A recipe for disaster
If pathogens survived this type of extinction event (which they do), they now face very favorable conditions: very little competition for resources, very little downward pressure from other microbes to prevent outbreaks, and no buffering forces from probiotics or algae to outcompete them. This is the worst place to start grow-out.
Day One post-ozone is when the microbiome is severely compromised. Water in this state cannot support high productivity or survivability rates. In fact, we’ve seen tanks promptly crash with a 100% mortality after adding water freshly treated with ozone. Some operations add probiotics and seeding products to the water at points during grow-out, which is a very prudent thing to do, but our research shows that adding positive counter-forces at this stage is far too late.
To counterbalance the destabilization of the microbiome, disinfection protocols should be optimized for both pathogen load reduction and the subsequent rehabilitation of the water before grow-out starts, especially in RAS systems.
Hatchery Feed & Management Vol 10 Issue 4 2022
MICROBIAL MANAGEMENT
Pathogen hitchhikers
In an ideal outcome, all pathogens would be killed off during the disinfection protocol, so the only challenge a farmer would face is restabilizing the water with an effective re-seeding protocol. Effective being the keyword. But many pathogens, especially Vibrio, are unwelcome hitchhikers that are accidentally introduced with newly imported stock.
We looked at what happens to the microbiome when the infected stock was added to pathogen-free water (Fig. 2). The microbiome in the tank water (sample 5.1) was stable leading up to the transfer of stock and showed good biodiversity. Biodiversity is a crucial driver of healthy water systems, and diversity means the tank

or pond water is more resilient to changes and less prone to future disease events.
The day after the infected stock was added (sample 5.1P), we can see two significant changes: the diversity dropped by almost 25%, and Vibrio became established in the tank.
The presence of Vibrio alone does not necessarily mean that a pathogen outbreak is guaranteed. Pathogens can be successfully managed with the right protocols in place. We consider the road to a full-blown pathogen event to be lined with a number of risk factors. The higher number of the risk factors, the higher the chance of a disease outbreak. In this case, the risk that this tank will experience a disease
40
Hatchery Feed & Management Vol 10 Issue 4 2022
Figure 1. Microbiome baselines three days before ozone disinfection and three days following the treatment showing a stable baseline prior and gross instability afterwards.
event is higher, but half the battle is won with awareness of the situation, followed by effective management that can bring the pathogen loads back down again to a low level.
Laying the foundation for high productivity
Water holds the key to high productivity, specifically the microbes that live in it. Together, they have the power to deliver high survival rates, booming growth, and a very healthy bottom line. If neglected, or unintentionally eliminated, all the benefits they deliver will be drastically reduced, along with profit margins.
Disinfection is ‘Ground Zero’ for establishing a pattern for success or failure for grow-out. Similarly, water used
for water exchange should also be rehabilitated and prepped for grow-out.
Optimizing disinfection protocols with particular attention paid to how inputs and treatments affect the microbiome are a prudent step to take in the successful management of water, especially in RAS systems.

More information:
Rachelle Jensen
CEO
Luminis Water Technologies
E: rachelle@luministech.com

Hatchery Feed & Management Vol 10 Issue 4 2022 41
Figure 2. After the introduction of Vibrio during stocking, diversity in the microbiome is reduced which increases risk of a pathogen outbreak.
Microbial water quality tools: Essential for maintaining an optimal and stable production environment
Stavros Panoutsopoulos, BactiQuant
Farmed fish production has been increasing steadily in recent years. The most crucial element influencing fish performance and health is water quality. To provide the best conditions for the fish being raised, the fish farmer must be able to monitor water quality parameters. Most operations seek to keep these water quality variables within ranges that promote maximum growth while utilizing less water and reducing waste. Nutrient inputs stimulate microbes and phytoplankton, which may lead to poor water quality. The amount of nutrients in the effluent is directly correlated with water retention time and hydraulic turnover rate (Tucker et al., 2005). As a result, the intensity and type of aquaculture systems being used directly affect the water quality.
Modern aquaculture production facilities, like RAS, operate at or close to maximum carrying capacity and have relatively complex circulation, aeration, and biofilter systems. Because of these systems’ high biological risk factors, vigilance in monitoring and prompt action are required to reduce mortality rates (Helfrich & Libey, 1991).
On the one hand, in RAS systems, a biological risk element is the continuous, high concentration of bacteria that surrounds the fish. Some of them are slowgrowing bacteria that commonly inhabit the intestines, gills, and skin’s mucus (Aam AL, 2015), while detrimental and pathogenic species can be found among the fastgrowing opportunistic bacteria (Allen et al., 2004).

MICROBIAL MANAGEMENT
Hatchery Feed & Management Vol 10 Issue 4 2022
According to Rojas and Tirado (2019), changes in water quality may lead to increased bacterial abundance and activity, reduce biological stability (Attramadal et al., 2012), and cause stress in the fish population (Harmin TD, 2009). Stressed individuals are more vulnerable to infection by dangerous, fast-growing pathogens (Raman et al., 2013). Yet, in aquafarm systems like RAS, monitoring microbiological water quality indicators has been impeded by time-consuming, ineffective, and/or complex tests (Rojas-Tirado, 2018).
Today, there is a growing demand for operational technologies that can be applied to RAS management to monitor microbiological water quality quickly and improve process effect understanding (Pedersen & Pedersen, 2016). On the other hand, hatcheries of catfish, salmon, and trout species face challenges from various fungi responsible for devastating infections on fish in aquaculture, fish farms, and hobby fish tanks. The most significant cause of economic losses in aquaculture is diseased fish, and oomycete (water molds) infections are second only to bacterial diseases in their impact (Meyer, 1991).
BactiQuant-water is a new microbial water quality parameter
The Danish company BactiQuant has created and patented a new microbiological water quality parameter called Bactiquant-water (BQW). The BQW method is a quick field test for fluorometric detection of a specific bacterial hydrolase enzyme activity. Gram-positive and gram-negative bacteria exhibit enzyme activity, representing all major bacterial taxonomic groups.
The process is easy, rapid, and highly reproducible (McKernan et al., 2012). The measurement can be performed on the spot, even under rugged conditions, and requires no extraction procedures. The US-EPA verified the BactiQuant method in 2012 in collaboration with Batelle (McKernan et al., 2012), and the EU awarded the technology with the seal of excellence in 2018. The technology has been used in research studies on RAS to monitor bacterial dynamics in the water phase, the impact of feed loading on microbial water quality, and bacterial activity on particles (Rojas-Tirado et al., 2019). Additionally, it has been used to monitor bacterial activity and conduct studies in the wetlands of a German trout farm (Naas, 2014).
How the measurement principle works
BactiQuant is based on a very sensitive fluorescence technology. The assay consists of three simple steps:

1) The bacteria in a water sample are concentrated using a Millex syringe-driven filter unit (PES, 0,22µm, express, Millipore).
2) A fluorophore-labeled enzyme substrate targeting a specific bacterial hydrolase activity is transferred to the filter unit using a syringe. The filter is saturated with the enzyme-substrate, and the enzyme reaction is initiated.
3) F ollowing the reaction step, the fluorophore produced from the reaction between the bacterial hydrolase activity and the enzyme substrate is flushed out of the filter into a cuvette. The fluorophore concentration is determined using a handheld fluorometer.
Hatchery Feed & Management Vol 10 Issue 4 2022 43
The fluorescence output from a water sample is linear with the time and volume of the sample. The result of a BactiQuant analysis is calculated based on standard conditions: Fluorescence output (FLU) per 250 ml of the water sample, reacted at 23oC for 30 minutes. This is defined as the BactiQuant-Water value. The BQW value is a proxy for the total bacterial presence in the analyzed water sample. The technology can detect particle-associated bacteria (PAB´s), slough of biofilm, and planktonic bacteria, providing a relevant and comprehensive measure of the total bacterial exposure in RAS, compared to the limited capabilities of the traditional methods. The sensitivity to bacterial concentration can be readily adjusted by changing the water volume filtrated and/or the reaction time. A typical protocol for an aquaculture water analysis is the filtration of a 50 ml water sample that reacted for 5 minutes at ambient temperature. The enzyme activity is calculated according to the following formula:
Opportunistic microorganisms have a lower risk of taking over a system where all parameters are maintained at steady levels, including water quality. Microbial water quality is essential not only for larvae and juvenile performance in hatcheries, which are the most vulnerable stages of fish development, but also for identifying problems in the later stages of the water cycle in a RAS system, such as the impact and optimization of sanitizing agents, the impact of feed on water quality, the effect of biofilter maintenance, etc.
With the help of BactiQuant-Water (for bacterial measurement) and FungiCount (for fungal measurement –able to measure micro fragments, spores, and hyphae), producers can generate their unique baseline of data and compare it to operational practices or altered assumptions, such as a new feed, feed spill, changes in operating practices for sludge drainage or recycling biofilters.
The baseline data will change throughout production. They will represent various fish species, growth phases (hatching, start feed), fish size, densities, feeding schedules, seasonal variations in source water quality, and operational routines like cleaning schedules for biofilters and tanks.

Why rapid microbial biomass assessment is a necessity and not a luxury
One of the key factors in reducing microbial risk in RAS systems is providing stable water microbiology.
In RAS systems, all components are equally crucial in ensuring the efficiency and safety of the system and the cultured species, like gears in a mechanical watch. BactiQuant allows the user to potentially monitor each gear and decide if changes need to be made since each gear contributes to fish welfare. Providing stable microbial water quality is an essential starting point that significantly contributes to better performance, increased growth, and reduced mortality. The user can
44
Assay parameter Value Limit of detection (LOD) 10 FLU Limit of quantification (LOQ) 30 FLU Relative standard deviation (RSD) < 7%* Inter assay reproducibility (RPD) < 7%* Hatchery Feed & Management Vol 10 Issue 4 2022
Table 1. Assay parameters for the BactiQuant products.
increase proactivity and verify stable water quality by optimizing processes, adjusting routines, and constantly monitoring microbial water quality.
Applications in aquaculture systems

While microbial biomass is a critical process parameter for water quality, the ability to do measurements in near real-time allows early detection of deviations in water quality. This enables the operator to quickly adjust production processes and operational routines to maintain a stable production environment. Secondly, BactiQuant enables users to optimize their water treatment processes by monitoring the microbial activity in Critical Control Points (CCP’s), such as before and after the water treatment chain. This will result in a deeper understanding of the efficiency of the installed water treatment technologies and allow for adjustments of the treatment steps in near realtime. Thirdly, BactiQuant’s products can be utilized to evaluate the impact different operating and handling processes have on the microbiome. Unsanitary
handling of fish (i.e., during vaccination), movement of fish in grow-out tanks, changing of equipment, feed type, feed frequency, etc., are critical examples of operational routines that can significantly disrupt the balance of the microbiome around the fish and allow for opportunistic microbes to proliferate out of control. Last but not least, as bigger RAS systems have multiple hatcheries and grow-out tanks, the technology can be used to benchmark production systems and, thus, assist operators in selecting and developing better production system designs.
References available on request.
More information:
Stavros Panoutsopoulos
 MSc, Sales Engineer
MSc, Sales Engineer
BanctiQuant
E: sp@bactiquant.com
Hatchery Feed & Management Vol 10 Issue 4 2022 45
Optimizing vaccination of fish
 Terje Tingbø , PHARMAQ part of Zoetis
Terje Tingbø , PHARMAQ part of Zoetis
Vaccination as a preventative tool
With industrialization follows increasing numbers of fish that need to be handled and cared for. Animal health and welfare, production efficiency and cost are key performance indicators, and vaccination has a positive effect on all of these by improving health, survival, growth performance and product quality. It also reduces the overall environmental and climate footprint by improving production efficiency. Vaccines for fish are most commonly oil-based formulations containing inactivated bacteria or viruses that are injected into the abdominal cavity. Some live
attenuated- and DNA-vaccines are available for salmonids, and these are administered into the abdominal cavity or muscle. Vaccination by immersion or oral administration via feed is not common, as it has so far proved challenging to achieve significant and lasting protection via these routes. Vaccines have proven highly efficient in salmon farming and significantly reduced or replaced the need for antibiotics. All salmon that are transferred to the sea in Norway are vaccinated, one fish can be protected against up to nine different bacteria and viruses, and as many as three vaccines may be injected simultaneously.
HEALTH
Hatchery Feed & Management Vol 10 Issue 4 2022
Manual vaccination of tilapia. Gloves are used for improved grip and protection against spines, and the needle guard helps prevent accidental self-injection.
Administration
The success of vaccination depends on proper delivery to the fish. Injection can be done either manually using hand-held syringes, or automatically by machines. The choice of method depends on fish numbers, farm infrastructure and economical aspects such as labor cost and ability to invest. In the salmon industry, automation has gradually replaced manual vaccination, and close to 90% of injections are today done by machines. For other species, such as European seabass and tilapia, manual vaccination is still by far the most common, but the use of machines is growing.

Principles of vaccination
Principles of vaccination are the same regardless of the method employed. Firstly, the fish population must be healthy and preferably of homogenous size. A licensed well-documented anesthetic should be used to ensure that the fish is motionless during injection and that it
wakes up and recovers safely. The accuracy of dose volume, injection site and depth are paramount to a good result. Advances in formulation technology have made it possible to reduce injection volumes from 0.2mL to 0.05mL since the 1990s. The smaller doses have contributed to fewer side effects, faster recovery and increased flexibility for the co-injection of vaccines, without reducing efficacy and duration of protection. On the other hand, the smaller volumes reduce the margins for dosing errors, which increases the importance of having accurate equipment and good quality control.
Injection site and depth
The optimal site of injection varies between species, and it is usually a defined area located along the midline of the belly. The length of the needle should ensure that the tip (bevel) fully penetrates the abdominal wall, taking into account the size variation
Hatchery Feed & Management Vol 10 Issue 4 2022 47
Automatic vaccination of tilapia at an AquaGenetics facility in Brazil (GenoMar Genetics Group). The anesthetized fish are placed on the belt by the operator and scanned by the machine which adapts the injection site and depth individually. After injection the fish are automatically graded into different channels according to pre-set size ranges.
in the population. Incorrect injection, either by location or length of needle, may cause injury to organs or incorrect deposit of vaccine, e.g. into the muscle or intestine. It is often recommended that feed is withheld for a defined period prior to vaccination in order to lower the risk of injection into the intestine and reduce metabolism (oxygen demand) and the accumulation of feces in the anesthetic bath. Vaccination should always be supervised by competent fish health personnel, and the recommendations of the vaccine manufacturer followed.
Manual vaccination
Manual vaccination is suitable for low to moderate numbers of fish and in environments with limited infrastructure. Vaccination tables are often manufactured locally in stainless steel. Various types and brands of hand-held syringes are available, including designs enabling simultaneous injection of two vaccines. Key characteristics are precision, ergonomics, durability, spare part access, ease of use and maintenance. Due to wear caused by intensive use and frequent de- and re-assembly for cleaning and maintenance, investment in quality equipment will always pay off. An important feature is the needle guard that helps prevent self-injection. Oil-based vaccines
are in general highly immunogenic for humans and can cause severe inflammation even after injection of small amounts. Regular breaks are recommended as the risk of both self-injection and inaccuracy tends to increase when people get tired.
Automatic vaccination
Automation is recommended for moderate to high numbers of fish in industrialized environments. Machines have become the gold standard for salmonids, and the technology is being successfully adopted for use also in other species. The least complex machines inject one vaccine in a pre-set injection point, while the more advanced ones are capable of delivering multiple vaccines with automatic adjustment of injection and sorting the fish by size after vaccination. The main advantages of automatic vaccination are efficiency, quality of injection, reduced handling and stress, operator safety and reduction of staff. One machine operated by 2-3 people may inject up to 8,000-9,000 fish per hour, equivalent to the capacity of eight vaccinators. However, machines require a minimum of infrastructure, efficient logistics, manufacturer’s support and competent operators to ensure that they reach their full potential.

48
Hatchery Feed & Management Vol 10 Issue 4 2022
Recommended area of injection and optimal needle length for vaccination of Atlantic salmon. The tip of the needle should fully penetrate the abdominal wall. A too long or too short needle may cause injury to organs or incorrect deposit of vaccine.
Quality control
A good quality system is key for successful vaccination. Procedures should be created in collaboration with the operating staff that will be applying them, and inspections should be performed regularly. Control points should include injection volume and calibrations, and evaluation of injection site, depth and vaccine deposit. The anesthetic bath must be checked and exchanged regularly, and the duration of vaccination and recovery time should be monitored and kept to a minimum to ensure animal welfare. Unnecessary handling, delays and stress may well trigger latent- or opportunistic infections. Inspections during manual vaccination should, as far as possible, be unannounced as vaccinators most understandably tend to sharpen when they see the QC person approaching. If incentive systems are employed, a focus on both quality and quantity is recommended. After use, all exposed equipment and surfaces should be properly cleaned to ensure biosecurity.
Facilities and fish flow
Thorough planning and supervision of the whole process from netting to recovery is a prerequisite. If the fish flow is not efficient, vaccination will not be either. Crowding and netting (or pumping) should be done as gently as possible, and time out of the water as short as possible. The fish must be motionless at the time of injection. Anesthesia is normally performed either manually with nets and buckets or mechanically by devices that transfer the anesthetized fish directly to the vaccination
table or to the machine. After injection, there should be a system that enables efficient distribution to tanks, ponds or cages. Modern facilities for juvenile production have designated areas for vaccination and infrastructure for flexible transportation of fish. Most suppliers of vaccination machines will recommend or supply the equipment required to set up a full vaccination line, e.g. pumps, holding- and anesthetic tanks and graders.
The people
Vaccine and vaccination technology is advancing rapidly, and as disease challenges become more complicated, more complex solutions will be needed. After decades of supporting the industry, we have learned that the people are the key. Without competence and dedication at the farm level, there will be no success no matter how advanced the technology you invest in. No farm is the same, they all have varying challenges and need different solutions. A close collaboration between farmers, farm personnel and suppliers of vaccines and vaccination equipment is therefore essential in order to optimize vaccination, facilitate innovation and support sustainability goals.
More information:
Terje Tingbø Head of Commercial Development Tilapia


PHARMAQ part of Zoetis
E: terje.tingbo@zoetis.com
Hatchery Feed & Management Vol 10 Issue 4 2022 49
The carp polyculture microbiome: How to break the status quo
WorldFish has been supporting the development of carp polyculture systems for several decades, particularly in Bangladesh. With microbiome health being increasingly associated with animal health and farm productivity, it has been identified as the next big opportunity to improve carp pond management, intensification of production and disease mitigation (de Bruijn et al., 2018; Gilbert et al., 2016). The rapid emergence of new technologies has, in addition, created knowledge that varies tremendously in its scope and detail, often resulting in conflicting views. Here, we look to summarize the state-of-the-art carp polyculture microbiome knowledge and highlight the opportunities that this knowledge base offers for the industry to advance beyond its standard practices.

An ancient tradition
Carp polyculture began in China during the Tang dynasty (618-907 A.D.) with the co-culture of bighead carp, silver carp, grass carp, common carp, and other species with diverse feeding habits (Hao-Ren, 1982). Polyculture results in the effective utilization of all biotopes within the ponds. Nowadays, carp is the fourth most cultivated fish species in aquaculture worldwide, accounting for 11.8% of global farmed fish production (FAO, 2022). Milstein (2055) reported that polyculture of Chinese carp has since been introduced to many countries to improve water quality and enhance fish productivity including Poland (Opuszyński, 1981), Bulgaria (Dimitrov, 1987), Hungary (Horvath et al., 1984), Israel (Milstein, 2005) and the USA (Chamberlain, 1993).
In line with the general trend in aquaculture, carp aquaculture practices are being intensified in order to meet the increasing demand for aquatic products. However, this intensification is accompanied by an increased risk of microbial disease outbreaks, which
can have a substantial influence on the profitability and sustainability of such operations (Faruk et al., 2004). The major bacterial pathogens of carp include Aeromonas hydrophila, Aeromonas salmonicida, as well as Flexibacter columnaris (Jeney & Jeney, 1995). Disease impacts the whole sector, including both small- and large-scale farmers, and has been identified as a major bottleneck for future sustainable growth. Currently, antibiotics and prophylactic agents are being used to try and control disease outbreaks and improve fish health, often based on little scientific justification, and as a result creating significant impacts on food safety, food quality and the environment.
50
Bui Ngoc Minh Ngan, Jérôme Delamare-Deboutteville, Colin Shelley, WorldFish, Jasmine Heyse, Ruben Props, Kytos
Hatchery Feed & Management Vol 10 Issue 4 2022
Figure 1. Rohu ( Labeo rohita ) G3 from Rajshashi Division, NW Bangladesh. G3 is a product of WorldFish’s Carp Genetic Improvement Program. Photo by Colin Shelley.
The microbial unknown
It has become evident that the sector must pivot away from risky and anecdotal management strategies to science-driven management plans. One of those scientific areas is the microbial ecology of carp polyculture ponds. This field studies the microbiome as a whole rather than only focusing on disease-bearing organisms. In our literature study, we found that many studies demonstrate an association between the host and rearing water microbiome composition (i.e. not only the potential pathogens). Effectively managing the rearing water microbiome will thus be important to reduce the emergence of diseases and improve carp health and production. Despite these largely empirical links, the research field still appears to be in its early stages, as most studies perform exploratory analyses
of the microbial communities of fish organs (e.g., skin, gill, gut) and the rearing environments. As a result, identifying interactions between so-called keystone taxa and their specific functions has proven difficult because of the complex structure of these communities, and the ever-changing environmental conditions in the open-air pond systems and diverse geographies.
Rearing water contains viruses, bacteria, microalgae, fungi and protozoans, and other higher plankton. The bacterial biome associated with the rearing water is often more diverse than the biome associated with the carps themselves (Chiarello et al., 2015). The dominant microbial taxa in carp polyculture systems might not be dependent on the composition and abundance of the microbial community in their aquatic environment, but on the host selection in shaping the internal and

Hatchery Feed & Management Vol 10 Issue 4 2022 51
Figure 2. Harvest of Rohu G3 in Rajshashi Division, NW Bangladesh. Photo by Colin Shelley.
Table 1. Studies on
Country Target systems Technology Dominated bacteria in pond Ref.
India Indian major carps
16S rRNA gene Genera: Actinomyces, Pseudonocardia, (Mukherjee (rohu, catla and mrigal) amplicon Sediminibacterium, Bacteroides, et al., 2020) polyculture ponds sequencing Exiguobacterium, Brochothrix Macrococcus, Alkalibacterium, Leuconostoc, Lactococcus, Shewanella, Trabulsiella, Acinetobacter, Psychrobacter, Luteolibacter
Family: Coriobacteriaceae, Planococcaceae, Planococcaceae, Halomonadaceae
Bulgaria Organic manured Morphological Dominated by free-living cocci bacteria (Kalcheva carp polyculture observation et al., 2010; ponds X. Li et al., 2021)
China Black carp
16S rRNA gene Phyla: Proteobacteria, Actinobacteria, polyculture ponds amplicon Bacteroides
sequencing Generia: Prochlorococcus, Bacillus, Polynucleobacter, Chryseobacterium, Novosphingobium, Acinetobacter, Flavobacterium, Oscillospira, Ruminococcaceae, Agrobacterium, Comamonas, Jan-thinobacterium, Rheinheimera
Grass carp, Crucian 16S rRNA gene Phyla: Bacteroidetes, Proteobacteria, (T.Li et al., 2015) carp and bighead amplicon Actinobacteria, Fusobacteria and carp polyculture sequencing Verrucomicrobia
Silver, bighead carp, 16S rRNA gene Phyla: Betaproteobacteria, (Tang et al., polyculture ponds amplicon Alphaproteobacteria, Gammaproteobacteria, 2021) sequencing Acidobacteria, Planctomycetes
Saudi Arabia Common carp and Morphological Phyla: Betaproteobacteria, (Tang et al., African catfish observation Alphaproteobacteria, Gammaproteobacteria, 2021) polyculture gram staining, Acidobacteria, Planctomycetes biochemical Species: A. hydrophila, Corynebacterium sp., (Uddin & testing C. Urealyticum, Edwardsiella sp., Al-Harbi, Micrococcus sp., S. putrefaciens 2012) Staphylococcus sp., Streptococcus sp., Vibrio sp., Unidentified G− rods
external microbiome. For example, a study by Zhang et al. (2019) found that the most abundant bacteria genus in the rearing water of grass carp and southern catfish polyculture pond is genus C39, which was rarely found in grass carp-related microbiome. The mechanism by which microorganisms and input factors, such as substrate, feeds, fertilizers, sanitizers and microbial products, enhance carp production remain largely unknown as causation and correlation are often used interchangeably.
Studies have shown microbiome differences of the same fish species related to the animal life stages, sample size, pond diversity and technical differences such as genome region and sequencing platform used
(Foysal et al., 2019). Such differences have also been shown to be influenced by diets, fish populations, rearing conditions and geographical environments (Tran et al., 2018). Thus, it is crucial to analyze the external and internal microbiomes of more polyculture fish species in order to understand microbiomeassociated host phylogeny with the characterization of ecological niche, metabolic specialization, and disease resistance. Moreover, many species in carp polyculture systems, each with their own feeding habits, actively control the microalgae composition of the pond. The variation in microalgae populations has been shown to be caused by variations in mixing conditions, carp species composition, feeds, and fertilizers. Pond
52
microbiomes in rearing water of carp polyculture systems.
Hatchery Feed & Management Vol 10 Issue 4 2022
eutrophication, caused by the microbial decomposition of unused feed and fish metabolic wastes can result in microalgae blooms which can also be harmful to fish, again highlighting the importance of understanding the complex factors impacting algal, as well as bacterial components of the microbiome.
Microbiome management: Where do we begin?
In summary, few studies exist on the microbial ecology of carp polyculture ponds. More high-quality research is required to discover and describe the whole microbiome diversity (e.g., bacteria, microalgae, virus, fungi, protozoa, etc). This work should focus on more concrete research questions, such as, how microbes associate with the nutritional content of the live feed, how they relate to the stabilization of water quality, and which factors create a non-pathogenic environment. Such targeted, hypothesis-driven research should complement the majority of exploratory research and will help in the creation of predictive theoretical frameworks that may lead to management practices that avoid invasive pathogens from conferring disease. We have identified three areas that show promise to impact carp polyculture management:
Technological improvements
A significant problem with the available carp microbiome data is the wide variety of findings from different laboratories, using different experimental designs and methodologies. It is important to note that most of the studies have relied on results from older, less-accurate methodologies (e.g., DGGE, agar plating) or, more recently, semi-quantitative nextgeneration sequencing. In recent years, it has been shown that combining data from these technologies with quantitative methods can yield surprisingly different insights into the compositional dynamics occurring in microbial ecosystems (Props et al., 2016). In the next few years, utilizing new tools, such as single-cell technologies, to undertake detailed highresolution sampling campaigns will produce a greater understanding of critical processes and interactions between important taxa in these environments.
Microbiome health baselines
Getting insights into the microbiomes of broodstock, eggs, larvael and water microbiome in both hatchery
and nursery systems will be extremely useful. This knowledge is important in shaping the rearing water microbiome of a system and in understanding their influences on the host (fish) microbiome. For example, fish egg microbiota shapes the larval microbiota (Olafsen, 2001) and may influence subsequent larval performance (Vadstein et al., 2013). The fish egg microbiome may be influenced by the holding tank, genetics (family effects) and egg disinfection procedures. Clearly, a better understanding of the factors influencing the egg microbiota of the fish can contribute information relevant to improving management and may help to identify the role of the microbiota in determining egg quality.
Product management
Little research has been done on the impact of supplemental microbial products on the microbiome community in carp polyculture systems. In carp polyculture systems, fish with diverse feeding methods may increase the stability of the system to prevent bacterial colonization (Zhou et al., 2017). Therefore, research is required to investigate the effectiveness of microbial products in improving microbiomes. While there may on occasion be a limited role for antibiotics (under veterinary advice), their effect on the general physiology of the microbiome, via the selection of a specific collection of clones and genes (Martínez, 2017) needs to be better understood. Studies to determine how antibiotics alter the microbiomes of culture systems will be useful.
References available on request.
More information:
MSc. Bui Ngoc Minh Ngan Intership WorldFish
E: n.bui@worldfishcenter.org

Hatchery Feed & Management Vol 10 Issue 4 2022 53
Industry Events
2023
FEBRUARY
8 - 9: Aqua Expo Santa Elena aquaexpo.com.ec
15 - 16: AquaFarm, Italy
23 - 26: Aquaculture America 2023, USA
MARCH
www.aquafarm.show
www.was.org
28 - 30: Aquafuture Spain aquafuturespain.com
APRIL 12 - 14: Vietshrimp Aquaculture International Fair, Vietnam vietshrimp.net
18 - 21: LACQUA 2023, Panama www.was.org
MAY
24 - 25: World Aquaculture and FIsheries Conference, Japan www.worldaquacultureconference.com
29 - June 1: World Aquaculture 2023, Australia www.was.org
AUGUST 22 - 24: Aqua Nor 2023, Norway
SEPTEMBER
5 - 7: Global Shrimp Forum 2023
18 - 21: Aquaculture Europe, Austria
www.aquanor.no
www-shrimp-forum.com
www.aquaeas.org
OCTOBER 23 - 26: Aqua Expo Guayaquil aquaexpo.com.ec
NOVEMBER 13 - 16: Aquaculture Africa, Zambia
www.was.org
54
Hatchery Feed & Management Vol 10 Issue 4 2022
PORDENONE EXHIBITION CENTER

International conference & trade show on aquaculture, algaculture and fishing industry



THE EVENT DEDICATED TO SUSTAINABLE PRODUCTION OF FOOD FROM WATER

CO-LOCATED WITH

ORGANIZED BY CONFERENCES & PRESS OFFICE BY
International conference & trade show for new growing systems, soilless and vertical farming.
The appointment of the entire algaculture supply chain. Exhibition area and conferences focused on cultivation, processing and use of algae and microalgae.
SHELLFISH
SUSTAINABLE
ALGACULTURE AQUACULTURE 4th Edition www.aquafarmexpo.it
FARMING
FISHING
15-16 FEBRUARY 20
23
6th Edition MAIN SPONSOR PARTNER 2nd Edition
















































































































 Technical advisor for Aquafoods.
E: anthonypaulbroadhurstfish@hotmail.com
Technical advisor for Aquafoods.
E: anthonypaulbroadhurstfish@hotmail.com

Barbara Hostins, Pranisa Suthianthong, Laurent Marien, Peter De Schryver, Inve Aquaculture (A Benchmark Company)
Barbara Hostins, Pranisa Suthianthong, Laurent Marien, Peter De Schryver, Inve Aquaculture (A Benchmark Company)



















 MSc, Sales Engineer
MSc, Sales Engineer
 Terje Tingbø , PHARMAQ part of Zoetis
Terje Tingbø , PHARMAQ part of Zoetis



































































